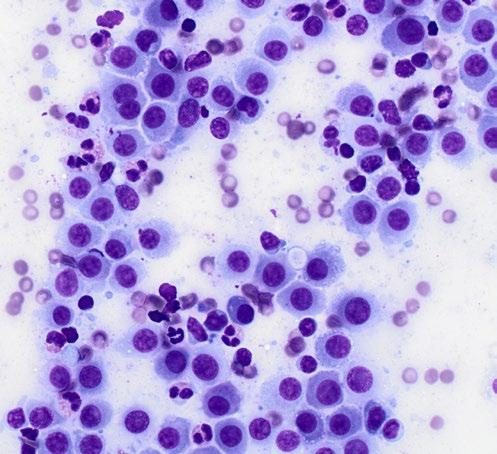

Hypothyroidism
Over-screened, over-diagnosed, over-dosed

![]()




Hypothyroidism
Over-screened, over-diagnosed, over-dosed

Guide Dogs use and trust Australia’s No.1 parasite protection and vaccine range for dogs*
Issue 317 | December 2024
Control & Therapy Series
PUBLISHER
Centre for Veterinary Education
Veterinary Science Conference Centre
Regimental Drive
The University of Sydney NSW 2006 + 61 2 9351 7979 cve.marketing@sydney.edu.au cve.edu.au
Print Post Approval No. 10005007
EDITOR
Lis Churchward elisabeth.churchward@sydney.edu.au
EDITORIAL ASSISTANT
Dr Jo Krockenberger joanne.krockenberger@sydney.edu.au
VETERINARY EDITOR
Dr Richard Malik
DESIGNER
Samin Mirgheshmi
ADVERTISING
Lis Churchward elisabeth.churchward@sydney.edu.au
To integrate your brand with C&T in print and digital and to discuss new business opportunities, please contact:
MARKETING & SALES MANAGER
Ines Borovic ines.borovic@sydney.edu.au
DISCLAIMER
All content made available in the Control & Therapy (including articles and videos) may be used by readers (You or Your) for educational purposes only.
Knowledge and best practice in this field are constantly changing. As new research and experience broadens our knowledge, changes in practice, treatment and drug therapy may become necessary or appropriate. You are advised to check the most current information provided (1) on procedures featured or (2) by the manufacturer of each product to be administered, to verify the recommended dose or formula, the method and duration of administration, and contraindications.
To the extent permitted by law You acknowledge and agree that:
I. Except for any non-excludable obligations, We give no warranty (express or implied) or guarantee that the content is current, or fit for any use whatsoever. All such information, services and materials are provided ‘as is’ and ‘as available’ without warranty of any kind.
II. All conditions, warranties, guarantees, rights, remedies, liabilities or other terms that may be implied or conferred by statute, custom or the general law that impose any liability or obligation on the University (We) in relation to the educational services We provide to You are expressly excluded; and
III. We have no liability to You or anyone else (including in negligence) for any type of loss, however incurred, in connection with Your use or reliance on the content, including (without limitation) loss of profits, loss of revenue, loss of goodwill, loss of customers, loss of or damage to reputation, loss of capital, downtime costs, loss under or in relation to any other contract, loss of data, loss of use of data or any direct, indirect, economic, special or consequential loss, harm, damage, cost or expense (including legal fees).
The C&T forum gives a ‘voice’ to the profession and everyone interested in animal welfare. You don’t have to be a CVE Member to contribute an article—submit your C&T article for publication here: cve.edu.au/submit-article
Join In!
The C&T is not a peer-reviewed journal.
We are keen on publishing short, pithy, practical articles (a simple paragraph is fine) that our readers can immediately relate to and utilise. Our editors will assist with English and grammar as required
I enjoy reading the C&T more than any other veterinary publication.
-Terry King, Veterinary Specialist Services, QLD
The C&T Series thrives due to your generosity.

Winners of Best Articles may choose either a CVE$100 voucher or a $100 voucher to Wild Scrubs—see page 21
Vouchers can be used towards membership fees or continuing education courses
Prize: A CVE$500 voucher
Senvelgo®—a Tale of Two Kitties!
Christopher Simpson
Winners
Prize: A CVE$100 voucher
Pythiosis of the Stomach in a Young Dog
Adrienne Easton, Bernice Blom
Pectus Excavatum in a Cat
Nerida Warburg
Prize: A CVE$300 voucher
Actinobacillus Dermatitis in a Young Steer
Victoria Ludlow & Jeremy Rogers

© Frank Gaschk
Thank you for your support in 2024
What a year it’s been! I’d like to acknowledge and thank everyone who has contributed to its success.
Our past CVE Director—Dr Simone Maher—who departed in April with our very best wishes.
Simone successfully led the CVE team since 2021 through many challenges including pivoting from an in-person conference to our first ever online-conference during the Covid years.
Note: The new CVE Director will be announced on CVE channels when recruitment has been finalised.
Our talented and dedicated tutors, presenters and speakers for providing high quality Continuing Education courses.
Our Sponsors & Advertisers whose financial support keeps our courses more accessible.
The CVE staff for keeping the ship on an even keel: membership grew, workshops and events sold out, 400+ vets from around the globe completed a 2024 Distance Education course, and many Vets, Vet Nurses & Vet Techs completed a TimeOnline, WebinarLIVE! or WebinarPLUS course.
Generous contributors to the C&T Series, in this its 55th year of publication—a major milestone for an altruistic forum.
Our Members—individuals and practices—who choose to support the CVE’s mission.
Participants who enrol in CVE courses.
The volunteer Vet Cookbook II team are working on the next edition —celebrating the joy of working in the profession. Details about how to order your copies and the launch coming soon…
Check the CVE website as new 2025 courses are being added daily. Don’t forget to enrol in the exciting February VC Feline Chronic Disease Management Conference at Early Bird rates – see page 34.
Season’s Greetings and best wishes for a relaxing holiday period.
cve.edu.au

Jacqui Norris Acting CVE Director
cve.edu.au/cve-awards
Read the complete citation on page 4 and Linda's response here.

2024 recipient of the T. G. Hungerford Award for Excellence in Continuing Veterinary Education
We’re delighted to announce Dr Linda Fleeman as this year's recipient for her profound and multifaceted contribution to veterinary medicine particularly to advancing the discipline of veterinary endocrinology
Acting CVE Director Dr Jacqui Norris presented this prestigious award to Linda ( pictured above left to right, respectively) at our recent highly successful ‘Paws Under Pressure: An Emergency Medicine Conference’ held in The State Library, Melbourne, in October. The framing includes a silver coin featuring a Goanna—the CVE’s motif—in tribute to Tom’s famous philosophy: Follow the Goanna Track to Success.
Tom’s philosophy was that the key to success was to identify an area of interest and devote time to it, listening, learning and building what he called a ‘tree of knowledge’. Now anyone familiar with a goanna can attest to the speed and agility with which they can scale a tree—to utilise Tom’s ‘Goanna Track’ is to construct the tree and ascend it like a goanna. But once up the tree the goanna doesn’t decide to spend the rest of its life in the canopy; it takes what it can, then returns to the ground and finds another tree. Tom’s point was that climbing that tree offered a unique vantage point from which other opportunities for growth and development could be identified.
It is in this spirit that the CVE offers courses in many different aspects of veterinary practice, in forms that suit everyone—whether you have a spare hour, day, month or year to invest in building your tree of knowledge. The CVE is dedicated to empowering the veterinary profession through education: enhancing confidence, competence, wellbeing and welfare globally since 1965.…
Linda joins the Honour Roll of past recipients of the Award, all giants in the profession:
Linda Fleeman
Not awarded
Terry King
Stephen Page
Not awarded
Stephen Holloway
Robin Stanley
Boyd Jones
Karon Hoffmann
Paul Canfield
Wing Tip Wong &
Glen Edwards
Victor Menrath
Russell Mitten
Not awarded
Richard Malik
David Church
Jill Maddison
Not Awarded
D.C. Blood
Graeme Allan
Richard LeCouteur
Reuben Rose
Susan Shaw
Christopher Bellenger
Jakob Malmo
R.R. Pascoe
The T.G. Hungerford Award was established upon the retirement of Dr Tom Hungerford OBE, who significantly contributed to the veterinary profession. The award honours the tradition of recognising excellence in continuing veterinary education.
“ So splendid is their performance; they adorn the awards for excellence now conferred upon them.
T.G. Hungerford
Dr Linda Fleeman is a worthy recipient of the Hungerford Award for 2024, recognised for her long-standing commitment to continuing veterinary education and her dedication to advancing the discipline of veterinary endocrinology. Her work has significantly influenced the field, benefiting both veterinarians and the animals they care for.
Dr Fleeman is a pioneering figure in veterinary endocrinology, renowned globally for her expertise in managing diabetes in companion animals. Over her distinguished career, she has redefined the standards of care for diabetic dogs and cats, combining innovative research with clinical practice to improve the lives of many animals. She is undoubtedly the leading authority on canine and feline diabetes in Australia.
As the founder and director of Animal Diabetes Australia— the world’s first veterinary service dedicated exclusively to the care of diabetic pets—Dr Fleeman has created a vital resource for both pet owners and veterinarians. Since establishing this specialised service in 2010, she has tirelessly advanced diabetes management, ensuring that pets receive high-quality care grounded in the latest scientific evidence. Her efforts have not only benefitted individual animals but have also raised the overall standard of veterinary care in Australia and globally, setting a new benchmark for diabetes management in companion animals.
Dr Fleeman’s contributions to veterinary medicine are profound and multifaceted. Her research has examined critical aspects of diabetes, including insulin sensitivity, glucose tolerance, and the genetic and environmental factors influencing the disease. Her studies on metabolic processes in obese dogs, along with her discovery that type 2 diabetes—common in humans and cats—is rare in dogs, have had significant implications. These insights have shifted how veterinarians approach diagnosis and treatment, leading to more effective care.
A key area of Dr Fleeman’s work is the nutritional management of diabetes. Her research has shown that individualised nutritional strategies are essential for managing diabetes in dogs and cats, revolutionising how dietary interventions are integrated into treatment protocols. Her work on insulin therapy, glucose monitoring, and glucose level variability has established
the foundation for modern best practices in diabetes management, equipping veterinarians with evidencebased strategies to navigate the complexities of this disease.
Beyond her research, Dr Fleeman is an outstanding educator and mentor. She has held influential academic positions at The University of Queensland and The University of Sydney, where her roles as a lecturer and senior lecturer have shaped the next generation of veterinary professionals. Her dedication to teaching is reflected in the many veterinarians she has mentored, guiding them through the intricacies of managing diabetic animals and inspiring clinical excellence. Dr Fleeman is also a prolific contributor to the scientific community, authoring numerous highly cited peer-reviewed publications and textbook chapters that make her work accessible to both academic and clinical audiences. Her international reputation as a leader in veterinary endocrinology is demonstrated by her regular appearances at prestigious national and international conferences. As a sought-after speaker, Dr Fleeman shares her insights with veterinarians worldwide, ensuring her innovative approaches to diabetes management reach a broad audience. Dr Fleeman has provided the Centre for Veterinary Education (CVE) with regular clinical updates on managing diabetic dogs and cats, contributing to numerous conferences and symposia, as well as the CVE’s Control & Therapy series.
In addition to her clinical and academic achievements, Dr Fleeman’s compassionate care for diabetic pets distinguishes her as an exceptional clinician. Her commitment to improving the quality of life for animals with diabetes is reflected in her thorough clinical practice and ongoing efforts to educate pet owners. She fosters a collaborative approach to diabetes management, empowering owners with the knowledge and tools to care for their pets effectively.
Dr Fleeman’s work has saved lives and brought peace of mind to countless families. Her compassionate approach to the emotional and practical challenges faced by owners of diabetic animals has earned her deep gratitude from the community, extending her influence beyond the veterinary clinic. Through her leadership, Dr Fleeman has built a legacy that will continue to shape veterinary endocrinology for years to come.
For her visionary leadership, transformative research, and compassionate clinical care, Dr Linda Fleeman is a deserving recipient of the Hungerford Award for 2024. Her contributions have significantly impacted the field of veterinary endocrinology, improving the lives of both animals and humans, and her work will undoubtedly inspire future generations of veterinarians.
The prize is a CVE$500 voucher
Dr Christopher Simpson BVSc MANZCVSc
Victoria Veterinary Clinics
Hong Kong
e. simpson_christo@icloud.com
C&T No. 6043

Dr Christopher Simpson is a graduate of The University of Melbourne, but has practiced in Melbourne, Sydney, Canberra, the US, the UK, and even the South Pacific island of Vanuatu!
Since 2015, however, he has found his spiritual home in Hong Kong, where he is attracted to the thrilling pace of life, Cantonese food, language, trail-running, and of course the fascinating caseload that only tropical Asia can offer! He is a member of the Australian & New Zealand College of Veterinary Scientists, has completed a Residency in Small Animal Internal Medicine at Melbourne University, and contributed scientific papers to the Australian Veterinary Journal, the Journal of Feline Medicine & Surgery, and several veterinary textbook chapters. He is also a regular contributor to the Control & Therapy Series, and enjoys sharing the rich and varied experiences of practicing in Hong Kong.
The is the story of our recent experiences with a completely new clinical modality for treating feline diabetes mellitus, with what hopefully includes some useful insights for fellow clinicians who may be starting out with these drugs, or wondering if they should…
Senvelgo® (velagliflozin) is one of two recently registered veterinary therapies belonging to the class of SGLT2 inhibitors (the other is Bexacat®, bexagliflozin). These medications work by inhibiting the Sodium-glucose cotransporter-2 in renal tubules, effectively lowering the renal threshold for glucose excretion. The clinical effect of these medications is to prevent or minimise hyperglycaemia via a mechanism completely different to insulin, which is much more familiar to most clinicians.
One distinction between SGLT2 inhibitors and insulins—and it cannot be overstated how important this distinction is—is
that SGLT2 inhibitors only treat hyperglycaemia, whereas insulin treats hyperglycaemia and by inhibiting the tendency for lipolysis to occur, insulin reduces the propensity for ketosis to develop. More on that later…
We have recently transitioned from using the original FreeStyle Libre continuous glucose monitoring system (CGMS) to FreeStyle 2. This allows our clients to link their FreeStyle sensors to our clinic’s LibreView® software, allowing us 24 hour access to all glucose data for all of our patients. This has given us the confidence to trial Senvelgo® in our hospital, knowing that we will be able to identify any major derangements in glucose results without relying on clients to call or revisit with us.
What follows, is what we learnt from our first two patients.
Here is Jun Jun, clearly thrilled to be participating in a brave new world of feline diabetes therapy.

Jun Jun was a newly diagnosed diabetic cat as of 2 weeks prior to starting Senvelgo®. She had undergone a comprehensive medical investigation which had determined that she had uncomplicated diabetes mellitus (DM) and had been managed with insulin glargine (Lantus®) prior to starting Senvelgo®. An important point here: the US FDA license for Senvelgo® is for use in newly diagnosed diabetic cats without previous use of insulin. The EU license, on the other hand, is for use in cats with or without prior insulin use, but without prior evidence of diabetic ketoacidosis (DKA). Again… more on that later…
Prior to starting Senvelgo®, Jun Jun was a bright, happy, stable cat, while receiving Lantus® BID, eating well, (Wellness CORE® canned diet) and with the sort of glucose curves that we have historically considered acceptable for cats on glargine (see below). In other words, a model patient for transition to an SGLT2i, at least according to the EU registration criteria.

for 3 days after starting Senvelgo ®
We had a long consultation with the owner. During this consultation we discussed the basic difference between insulin and Senvelgo®, and in particular we discussed the fact that Senvelgo® does not prevent ketone body formation (in itself), but rather relies on residual insulin production from the islets to take care of this task. We provided the owner with dipsticks to test the urine for ketones at home, and scheduled revisits at days 3, 7, and 14, according to the manufacturer’s guidelines.
We then watched in fascination as the data started to upload to our LibreView® portal…
The data immediately exceeded our wildest expectations. The chart above shows the 3 days prior to, and the 3 days after, starting Senvelgo®. The glucose results on insulin demonstrate a fairly typical peak and trough (nadir) pattern, with a moderate but acceptable degree of variation from dose to dose. The Senvelgo® was started on Tuesday 10th September at 8.00 am. In under 4 hours, the glucose dropped into the normal range, and remained fixed within it for the following 7 days (not all shown).
In addition, Jun Jun remained clinically normal, bright, and with a good appetite at all times. As per our instructions, the owner tested Jun Jun’s urine for ketones with the test kit shown ( Figure 2), and tests were negative at all times.
We also scheduled tests of the blood ketones with a handheld ketone test kit ( Figure 3 ), prior to treatment, and on day 3, and on day 7.
It is important to note here that the urine and blood test kits do not measure exactly the same things. Urine test kits test for acetone and acetoacetate, whereas blood test kits test for β-hydroxybutyrate. All ketones are produced as a consequence of peripheral lipolysis. SGLT2i’s are highly effective at lowering blood glucose but (unlike insulin) have no effect on preventing ketone production.

Let’s dig deeper into this aspect of the pathophysiology: Insulin deficiency plays a crucial role in the formation of ketone bodies through a process called ketogenesis. When insulin levels are low, the body’s fat cells (adipocytes) begin to break down stored triglycerides into free fatty acids (FFAs) through a process called lipolysis. This occurs because insulin normally inhibits hormone-sensitive lipase, the enzyme responsible for breaking down triglycerides. Without insulin’s inhibitory effect, lipolysis increases dramatically.
The free fatty acids released from adipose tissue are then transported to the liver. In the liver, the lack of insulin and the presence of counter-regulatory hormones like glucagon promote the oxidation of these fatty acids. As fatty acid oxidation increases in the liver, it leads to an accumulation of acetyl-CoA. Under normal circumstances, acetyl-CoA would enter the citric acid (TCA) cycle. However, in the absence of insulin and the presence of high levels of glucagon, the enzyme pyruvate carboxylase is activated, diverting oxaloacetate away from the citric acid cycle and into gluconeogenesis. The high levels of NADH resulting from excessive β-oxidation of fatty acids inhibit the citric acid cycle. As a result, the excess acetyl-CoA is redirected into ketone body production. The liver converts acetyl-CoA into three main ketone bodies: Acetoacetate, β-hydroxybutyrate and Acetone.
The lack of insulin also leads to an increase in counterregulatory hormones such as glucagon, cortisol, and catecholamines. These hormones further stimulate lipolysis and ketogenesis.
Without sufficient insulin, cells cannot efficiently take up and use glucose for energy. This forces the body to rely more heavily on fatty acid oxidation and ketone body production as alternative fuel sources.
In summary, insulin deficiency leads to increased lipolysis, enhanced fatty acid oxidation in the liver, and
The chemistry of the reagent pad detects acetone and acetoacetate.

the diversion of acetyl-CoA into ketone body production. This process is further amplified by the presence of counter-regulatory hormones and the body’s inability to efficiently use glucose for energy.
In cats, blood concentrations of β-hydroxybutyrate (BHB) are increased substantially before urinary acetoacetate is detectable. Accordingly, blood testing for BHB is an earlier and more sensitive screening test for ketosis than urine dipsticks.
For these reasons, we tested blood BHB concentrations on days 0, 3, and 7. And a good thing we did, too… on day 7, there was trouble in paradise…
Shown ( Figure 3 ) is Jun Jun’s ketone (BHB) result on day 7. Normal, non-diabetic cats either have no detectable ketones, or very low levels, 0.1-0.2 mmol/L. The recommendation for abandoning treatment with Senvelgo® is any value > 2.4 mmol/L.
Another important point is that ketones and diabetic ketoacidosis (DKA) are not exactly the same things. Ketones are acidotic, i.e., they tend to result in acidemia, but clinically relevant acidemia doesn’t occur with low levels of ketones. If ketones are high enough for long enough, then full-blown DKA results.
Jun Jun was completely asymptomatic, urine dipsticks were negative for ketones, and the only way we would have detected a problem was by testing the ketones in blood. If this had not been done, then the ketones would have increased until DKA occurred, and even then, the glucose would have been normal. This syndrome is called euglycemic DKA, or eDKA for short.
The single most important principle to be aware of when starting SGLT2 inhibitors is the principle of eDKA. Totally unlike insulin therapy, cats on SGLT2i’s can develop eDKA with no hyperglycaemia, and no clinical signs, until they suddenly crash in a full-blown acidemic crisis. From colleagues we have spoken to in the US, when this occurs, it can be incredibly rapid, dangerous, and expensive and difficult to reverse. In some cases, patients can be lost.
Part of the reason we chose Jun Jun to be our first patient is that we knew the owner to be extremely diligent and reliable with her observations. Sure enough, between our instructions and her compliance, an elevation in ketones was detected before eDKA occurred, and major problems were averted.
Jun Jun was transitioned back to glargine insulin (Lantus®) and continues to do well.
The sartorially splendid Milk was our second Senvelgo® patient. Just like Jun Jun, Milk had a thorough

work-up prior to treatment, and was determined to be an uncomplicated, newly diagnosed diabetic. Also like Jun Jun, Milk had been on Lantus® for 2 weeks prior to starting Senvelgo®. Milk was managed according to an identical protocol as Jun Jun, i.e., the owner took urine ketone dipsticks daily, and we tested blood ketones on days 0, 3, 7, and 14.
Milk, however, was more fortunate than Jun Jun. The glycemic results were similarly spectacular. Within hours of the first dose, the glucose became normal, and remained within the normal reference interval at all times since then (Table 2.). Urine ketone dipsticks have been normal (negative) daily since Senvelgo® was started, and in-clinic blood tests for ketones (BHB) were 0.1, 0.1, 0.2, and 0.1 mmol/L respectively at days 0, 3, 7, and 14.
At the time of writing, Milk is clinically asymptomatic, insulin-free, and managed with daily oral Senvelgo® therapy.
So why is Milk euglycemic without ketones when Jun Jun was euglycemic with ketones? The answer is likely to be that Milk has some remaining functional pancreatic beta cells, whereas Jun Jun has either none, or very few (i.e., insufficient).
There is a significant disparity between the amount of insulin required to control glucose and the amount required to prevent lipolysis/ketosis. Cats with some residual beta cell function may suffer from hyperglycaemia, but not ketosis, whereas cats with absent to zero beta cell functioning are likely to suffer hyperglycaemia and ketosis. In the sequence of events in most cats with what used to be called type 2 diabetes, at first when there is increased insulin resistance and limited glucose toxicity, there is some residual beta cell function remaining.
As a result, cats with zero beta cell function (like Jun Jun), cannot be managed with Senvelgo® alone, because Senvelgo® does not prevent peripheral lipolysis and hence ketosis at all, and such cats do not have enough beta cell function left to prevent it; but cats with low

but non-zero beta cell function (like Milk) can do really well on Senvelgo®, because the Senvelgo® controls the glucose, and they have enough residual beta cell function to prevent ketosis, and furthermore, this should further improve when the glucose toxicity is reversed.
So, what is the take home message? SGLT2 inhibitors are a classic example of a drug which needs to be understood to be used safely. If we select our patients, educate our clients, and monitor our cases diligently, they have the potential to be a game-changer for a certain cohort of our feline diabetic patients.
Used carelessly, or with incomplete understanding or compliance, they have a potentially extremely nasty sting in the tail…
courtesy of Linda Fleeman BVSc PhD MANZCVS
Animal Diabetes Australia
President of the Veterinary Endocrine Society of the Pacific & Asia (VESPA)
Dr Chris Simpson’s article, Senvelgo® – A tale of two kitties!, provides detailed and illuminating insight into
a wonderful new treatment for feline diabetes that will soon be available in Australia and New Zealand. The contrasting outcomes of his first two cases show exactly why Senvelgo® will not be an option for all diabetic cats. Importantly, he provides specific guidance about how to identify cats that will respond well to this treatment versus cats that cannot be safely treated with Senvelgo® because they do not have enough beta cells.
The first take home message is that it is MANDATORY to follow the manufacturer’s instructions regarding ketone monitoring during the first 2 weeks of treatment with Senvelgo®. These are not recommended guidelines. They are simple and fool-proof, but are not optional. In Australia and New Zealand, we are fortunate to be in a position to learn from overseas experience before release of Senvelgo® here. There is already ample experience in North America, United Kingdom, and Europe of cases of life-threatening diabetic ketoacidosis (DKA) if ketones are not monitored as recommended by the manufacturer.
The next point to consider is:
How Should We Monitor These Cases After The First 2 Weeks of Treatment?
Senvelgo® must be discontinued in all cats that develop ketosis during the first 2 weeks of treatment. These cats
must all be treated with insulin instead. In theory, these cats might have a lower chance of achieving diabetic remission than the overall diabetic cat population because they likely have little beta cell capacity. However, this is not yet known, and so standard protocols of insulin treatment and monitoring are recommended.
For cats treated with Senvelgo, there is no requirement to monitor for hypoglycaemia. This is a major advantage of treatment with SGLT2 inhibitors and means that there is no requirement for glycaemic monitoring beyond confirming that there are no clinical signs of diabetes. This can be simply achieved using the ALIVE Diabetic Clinical Score, which is based on the answers to 4 questions regarding:
1. Unintended weight loss,
2. Polyuria and polydipsia,
3. Appetite, and
4. Attitude/activity esve.org/alive/search.aspx
Put simply, there will be no need to perform any other glycaemic monitoring if the cat’s clinical signs are controlled with Senvelgo® to a level that is acceptable to the cat’s owner.
For cats treated with Senvelgo® for longer than 2
weeks, it is recommended to check blood or urine ketones whenever the cat is unwell. This is because DKA (euglycaemic or hyperglycaemic) might occur in association with illness. For many owners of cats treated with Senvelgo®, the best approach might be to routinely check blood ketones once weekly and/or urine ketones twice weekly on an ongoing basis. This will facilitate early detection of ketosis and provide reassurance for owners prone to anxiety about their cat or who like to feel in control. It also will ensure that the owner will be more likely to:
1. Remember how to check for ketones if they need to, and
2. Inform clinicians in emergency centres that it is necessary to check ketones in their cat.
I echo Dr Simpson’s conclusion. Senvelgo® will provide a simple, safe, efficacious, oral, once-daily treatment for a proportion of diabetic cats, but, just like insulin, this drug needs to be understood to be used safely. I recommend that you save a copy of this C&T article so that you can review it before you use Senvelgo® for the first time.

Visit cve.edu.au/Senevelgo to print or file this C&T article.
Dr Adrienne
Easton BVSc
Dr Bernice Blom BVSc
Kuranda & Mareeba Veterinary Services
e. kurandavets@kurandavets.com.au
m. 07 4093 7283
C&T No. 6044
Introduction
Pearl is a 24 kg 1-year-old spayed female Boxer from Kuranda in Far North Queensland. She presented on Tuesday 9th April with a 3-week history of intermittent vomiting which had progressed overnight to vomiting blood-tinged fluid.
Pearl’s clinical exam showed pale pink dry mucous membranes, CRT <2 sec, HR ~120 bpm = PR, no murmurs or irregularities, lung fields clear. Abdominal palpation had an empty feel, was relaxed and not painful anywhere,

no organomegaly was palpable. Her temperature was 38.2°C and her general demeanour was very bright, happy and active.
Due to the length of time the vomiting had been occurring, it was elected to run blood work on Pearl.
The main changes seen on blood work were mild regenerative anemia (HCT 0.32 L/L), neutrophilia (23.61 x 109/L) mild Eosinophilia (1.4 x 109/L), mild elevation of amylase (1649 U/L) and lipase (3212 U/L) activity and a substantial elevation in C-Reactive Protein (CRP; 76.7 mg/L).
Pearl was given a Cerenia injection (1mg/kg) subcutaneously and a Clavulox injection (20mg/kg) subcutaneously and sent home on nil per os overnight and was to return the next day for IV fluids and ultrasound examination of the abdomen.
Pearl returned the following afternoon still extremely bright and was placed on IV fluids overnight prior to ultrasound.
Overnight, Pearl ate chicken and produced 2 small areas of brown fluid regurgitations. When she was observed ‘vomiting’, Pearl was apparently regurgitating with no force behind the production of liquid.
An abdominal ultrasound was performed on Thursday 11th April. The ultrasound showed an area of stomach wall that was thickened up to 2cm in places, with hyperechoic tissue causing loss of stomach wall layering in the region of the thickening. No other abnormalities were seen on ultrasound. Abdominal radiographs were also taken but did not show anything not visible on ultrasound.
It was recommended to the owner that we take Pearl to an exploratory laparotomy to assess the affected area of the stomach. Endoscopy was considered, but due to the thickness of the gastric wall it was decided we would be likely to get better and more representative biopsy samples via a laparotomy.
An exploratory laparotomy was performed on Thursday April 11. The patient was pre-medicated with methadone (0.3mg/kg) IM. Anaesthesia was induced with propofol IV to effect and maintained with isoflurane in 100% oxygen. The ventral abdomen was clipped and prepared with chlorhexidine and an alcohol solution with the patient in dorsal recumbency.
A midline incision from the xyphoid to 10 cm caudal to the umbilicus was made. The falciform ligament was removed to improve visualisation. Bladder, kidneys and





2. Ultrasound images showing loss of layering and profound thickening of a portion (stars) of the gastric wall
intestines were examined with no abnormalities noted. The stomach was palpated and found to be hard on the ventral surface. The stomach was exteriorized and 2/0 PDO was placed through the stomach and used as stay sutures. The stomach was packed off with abdominal sponges to help with positioning and prevent abdominal contamination. The ventral side of the stomach palpated as a large hard area approximately 10 cm x 14 cm, extending from just below the fundus across the body to the pyloric antrum. An Incision was made in the stomach in tissue which felt normal, close to the greater curvature of the stomach. Suction was used to remove the fluid contents of the stomach.
The side of the stomach affected had a large ring of very thick hard material greater than 2 cm in thickness surrounding a hard center with loss of rugae and signs of ulceration. Multiple biopsies were taken from the affected tissue from inside the stomach. A decision was made not to take full thickness biopsies due to concerns about failure of the biopsy sites to heal. The stomach was closed using 3/0 PDO in 2 layers and an omental patch was sutured over the incision. The abdominal muscles


and subcutis was closed with size 0 PDO in a continuous pattern and skin sutures were placed with a Ford interlocking suture pattern.
Recovery from anaesthesia was uneventful and pain relief was continued with methadone. NSAIDs were avoided due to the extensive ulceration seen in the stomach. Clavulox (20mg/kg) SID by injection was continued as well as metronidazole IV (10mg/kg) BID and maropitant IV (1mg/kg) SID.
Friday 13th April the patient was extremely bright and was offered food and water and ate and drank well. She was started on oral Metronidazole (10mg/kg BID), Clavulox (11mg/kg BID), Omeprazole (1mg/kg BID), Maropitant (3mg/kg SID) and sucralfate (1 gram BID), and was discharged that evening.
Pathology results were received on April 17th showing severe eosinophilic gastritis with intralesional fungal/ oomycete organisms most likely pythiosis. Further classification of the lesions would require fungal culture +/- PCR of fresh tissue.
Histopathology
Macroscopic
Stomach: The specimen consists of 3 pieces of tissue measuring in aggregate 18 x 11 x 8 mm. Largest 2 pieces each trisected with fragmentation.
Eight sections of gastric wall were examined. These revealed severe expansion and effacement of the deep lamina propria and submucosa by dense coalescing sheets of inflammatory cells within a reactive fibrovascular stroma. Inflammatory cells were predominantly eosinophils with fewer macrophages and multifocal lymphonodular aggregates. Multifocally, within these inflammatory foci, was a low to moderate number of poorly delineated fungal/oomycete organisms occasionally surrounded by small amounts of hypereosinophilic coagulum (Splendore-Hoeppli reaction). No neoplastic tissue was identified.
Severe eosinophilic gastritis with intralesional fungal/ oomycete organisms.
This is an inflammatory lesion with intralesional fungal/algal organisms. These are difficult to further characterise in the H and E sections and a special stain will be performed to attempt to further describe these organisms. Ideally, fungal culture of fresh tissue provides the most definitive characterisation of these organisms. There is no evidence of neoplasia in the sections.
Grocott: Moderate numbers of intralesional branching/ budding non-septate hyphae (3-8 µm diameter) are evident.
This is most consistent with an opportunistic invasive oomycete infection and given the eosinophilic inflammation I would place pythiosis high on my differential list. Further classification would require cultures +/- PCR of fresh tissue.
A treatment plan was developed using a triple pronged approach.
Pearl commenced posaconazole 5mg/kg SID, Azithromycin 10mg/kg SID and a fungicide called Metalaxyl-M (Solitaire 240 ME fungicide 240 g/L) starting with 2mg/kg BID orally and increasing to 5mg/kg BID.
Initially the patient was boarding in hospital; when sent home, she became very active and began regurgitating constantly and refusing to eat for the owner. The owners declined further surgery to place a jejunostomy tube, so we hospitalised her and when she was quiet, she appeared to be able to keep food and liquid down with the occasional regurgitation of brown liquid.
Pearl is now at home 3 weeks after starting the Metalaxyl. She is currently on Metalaxyl M 5mg/kg BID, Posaconazole 5mg/kg SID, Azithromycin 10mg/kg SID, Carafate 1 gm BID, Metoclopramide tablets 20mg BID and Carafate 1gm BID. She is still struggling with anaemia from the large lesion in her stomach but has regained appetite and only occasionally regurgitating.
One month post starting Metalaxyl, PCV is now 28, the dog has gained 1 kg in weight and ultrasound shows visible areas of thickened wall smaller than prior to biopsy. Pearl continues to have episodes of regurgitation and vomiting intermittently, no blood is visible in vomit and faeces have returned to normal colour.
Pythiosis is very common in horses in our region and our clinic has treated many swamp cancers in the past with iodides (potassium and sodium Iodide) but we have never diagnosed intestinal pythiosis. The information on previous treatments of gastric/intestinal pythiosis mainly revolving around itraconazole and terbinafine, or intravenous amphotericin B, have been often unrewarding and have as low as 25% survival rate. Our treatment plan was developed with the help of Dr Richard Malik who was able to direct us to the antifungal Metalaxyl-M and its use in treatment of intestinal pythiosis. We expect that treatment will need to continue for 6 months or more to provide best outcome. Response 1 month post initiation of treatment is encouraging but by no means a guarantee of cure.


Pearl had a check up on 12.9.2024 and approximately 5 months after starting treatment her weight is now 24.2 kg. Pearl is extremely bright, alert, active and is eating very well. We sedated her to perform ultrasound to assess her progress.
The Ultrasound ( Figures 4) shows there are still some areas with thickening but they are much smaller than previously. I have recommended she stay on medication for another 3 months and then we will repeat the ultrasound.
We have continued Pearl on posaconazole 5mg/kg SID, Azithromycin 10mg/kg SID and Metalaxyl-M (Solitaire 240 ME fungicide 240 g/l) 6mg/kg BID.
Key reference
Billings P, Walton S, Shmalberg J, Santoro D. The Use of Mefenoxam to Treat Cutaneous and Gastrointestinal Pythiosis in Dogs: A Retrospective Study. Microorganisms. 2023 Jun 30;11(7):1726. doi: 10.3390/ microorganisms11071726.
Dr Ester Quilez
Specialist in Veterinary Clinical Pathology
University Veterinary Teaching Hospital Camden Veterinary Pathology Diagnostic Services
Sydney School of Veterinary Science
e. ester.quilez@sydney.edu.au
C&T No. 6045
A 16-year-old, male neutered American Staffordshire Terrier was referred to the surgery department of the University Veterinary Teaching Hospital Sydney with history of a fast-growing cutaneous preputial mass ( Figure 1) measuring approximately 3 x 2 x 2 cm. The dog was otherwise well in itself, and the only significant clinical sign was a change in the urination pattern. On physical exam, the mass appeared alopecic, irregular and ulcerated. A large subcutaneous mass on the caudoventral left of the midline (inguinal area) was also detected (approximately 6x6cm in size). The superficial cervical, popliteal and inguinal lymph nodes were enlarged. The blood work showed a mild normocytic normochromic non-regenerative anaemia. The owner declined FNA of the mass but consented to FNA of the lymph nodes and excision and histopathology of the preputial mass. Further peri-operative diagnostics to assess for the presence and extent of metastatic disease were also declined.
FNAs were obtained from the large inguinal mass (suspected enlarged inguinal lymph node) and stained with rapid Romanowsky stain (Rapid Diff, Australian Biostain). Images of the cytology smears are shown below in Figures 2 and 3
1. What are the main diagnostic possibilities based on the gross appearance of the cutaneous preputial mass?
2. What is your diagnosis of the inguinal mass based on the cytology?
3. Which further diagnostics would you recommend?
Email your answer to cve.marketing@sydney.edu.au
The winner of the best and most complete answer wins a CVE$300 voucher.

With our compliments

The second edition Vet Cookbook features over 100 exciting recipes (including the fun and the quirky!) and beautiful artwork that showcases the diversity and talent of those working in the veterinary profession— as illustrated by Dr Tamara Mobb’s jaw-dropping cake decoration depicting an emergency and critical care patient.
Best of all, it gives voice to those working as Vets, Vet Nurses and allied professionals to express why they LOVE their work.
"I truly believe that being a vet is the greatest profession on earth.
It can be hard to maintain this positive spirit and see the extraordinary that lies in each and every day, especially when it feels that we are being constantly told that the profession will grind us down. Of course, there are days that it is horrendous — but within every day, there is always something good… working together in a collaborative flow. It's incredible.
-Dr Karen Teasdale
To find out how to get your hands on a copy/ies of this sure-to-be treasured, collector's item, watch your emails and/or cve.edu.au

Dr Nerida Warburg BVSc(Hon)
The Cat Clinic Hobart
150 New Town Rd
New Town TAS 7008
e. moira@catvethobart.com.au
t. +613 6227 8000
C&T No. 6046

Fliss is a 7-month-old spayed female Domestic Shorthair cat. She presented to us on the 2 January 2024 from a rescuer who had been looking after her for 10 days and who had concerns about her abnormal chest shape, ‘slowing down’, not gaining weight and increased effort breathing with mild exertion. She had a very high flea burden. On physical exam, she had abnormal thorax on palpation with a very inverted sternal area. She was purring with increased respiratory effort. BCS was 3/9, weight 750g. HR=200 BPM. The rest of her clinical exam was normal.
She was assessed as a case of severe pectus excavatum. On CBC, her PCV was found to be 0.18 L/L, total plasma protein concentration 57g/L; the anaemia was suspected to be from the heavy flea burden she had when found. Radiographs were taken under sedation which showed marked compression of the thoracic cavity with the heart displaced to the right side ( Figure 2).
1. External splint—in place for at least 4 weeks. High risk of complications e.g. damage placing sutures, re-expansion pulmonary oedema.
Watch the video of Fliss breathing prior to surgery cve.edu.au/fliss
2. Delay surgery until bigger / stronger / improved PCV (assuming flea-related); however, we were concerned she may not survive long without correction
3. Euthanasia—quite reasonable given severity
Advice was received from Dr Rhett Marshall that a splint was a good option in a young kitten with a flexible thorax. This would be kept in place for around a month. He had treated several cases successfully and expected good outcomes. The initial placement of sutures through the sternum was the highest risk, being compressed so closely to the heart and major vessels.
Alfaxan IV to effect, V-tech tube and isoflourane general anaesthetic (GA).
3 stay sutures (3-0 pdm) were placed percutaneously under the sternum and xiphoid process. The initial suture was used to traction the sternum away from underlying structures.
Loose sutures were thrown to secure to body, with the ears left long.
The ears were then looped through the cast which was moulded to the correct shape using a 20 mL syringe and pulled tight to pull sternum ventrally. No complications were encountered at this stage. Post-op radiographs showed marked improvement in the position of the sternum. RR was 60/minute.
Fentanyl CRI 2µg/kg/hr for ~24hrs then weaned off Fentanyl patch 1/4x 25µg/hr =6.25µg/hr placed on tail Started on ketamine CRI 0.3mg/kg/hr in recovery
Fliss was fostered by me, after a few nights with one of our other vets. She initially showed some discomfort with the splint but after a few days became energetic and playful. Recheck examination on 5 days post surgery showed RR=56 with normal effort. RR settled when asleep but was still consistently elevated when awake and there was increased effort with exertion. Her weight was 910 g. Fliss received her first vaccination.
On 16 January ~2 weeks after the splint was placed, Fliss had normal respiration, and her weight was 1.05 kg, BCS=3/9. She had a repeat GA and sutures were tightened over a 5 mL syringe casing to place more pressure on the sternum and draw it further away from



the spine. She had a repeat fentanyl patch, methadone q4-6 hrs and micro dose ketamine for analgesia as there was some pain post procedure.
Fliss had her brace removed on 29 January, weight 1.2 kg BCS 3/9. She had multiple wounds from the brace pressure points and needed a GA to examine, clean and suture wounds closed. Chest radiographs showed marked improvement. There was a lucent hole in sternal bone from where suture had been placed. Fliss was placed on 5 days amoxyclav to cover infection. She was very comfortable with the brace removed and no further pain relief was needed.
Fliss had her second vaccination on 13 February and had grown to 1.55 kg with BCS 4/9.
Fliss was desexed on 20 March; there were no concerns at home. Weight 1.97 kg, BCS 4/9, a ventral dip in thoracic spine was visible and a small protuberance from the sternum was palpable and thought likely from where the sutures were placed. Her clinical examination was otherwise normal, RR=28/min.
Fliss has stayed on permanently at the Warburg residence after befriending and bewitching the other foster fail tabby cat, dog and 3 small boys. She has not looked back and continues to be a flighty, affectionate little beast. The ventral dip in her sternum is no longer evident and you would not know she had any issues as a kitten.
On reflection, we feel the brace would have been better if slightly wider sitting 2/3 to 3/4 up the thorax with more padding to reduce pressure sores. She may have had less pressure sores if strictly confined to reduce rubbing on the brace. There is a very good Clinicians Brief article with step wise instructions for brace placement (see link below). Overall, we were very happy with the great outcome and we expect no long-term effects or concerns.


Read External Splinting for Pectus Excavatum in Kittens from Clinician's Brief: cve.edu.au/splint


Are you aware of the financial, environmental, or labour

Your clinic likely sterilizes surgical instruments and implants using one or more of the following methods:
Single-use blue wraps around some form of basket
Single-use paper or sealable plastic pouches
Reusable cloth drapes
Reusable rigid sterilization containers
Single-use wraps (or blueys) are inexpensive and widely available. However, they are designed for one-time use and then discarded, contributing significantly to a practice’s waste stream, which ultimately ends up in landfills. Australians produce approximately 21.6 billion tonnes of landfill each year, with hospital single-use goods being a notable contributor.¹ Additionally, blueys cannot act as rigid barriers, and sharp instruments can perforate them, compromising kit sterility. If accidental perforation occurs, it’s unlikely you would even be aware of it. Wrapping a kit also takes time, which is something most nurses have in short supply.
Single-use paper or sealable plastic pouches are also inexpensive and commonly available. They allow small quantities of instruments to be contained and sterilized but also end up as landfill. Being non-rigid, they are also susceptible to accidental perforation.²
Reusable cloth drapes are relatively expensive and have been used for many decades. Although they are disposed of infrequently, they need to be washed and dried after each use. Consider the water, detergent, electricity, and nursing time required for each use.³
Reusable rigid sterilization containers are typically made of aluminium. While they require a larger upfront cost, their lifespan is incomparable, as rigid containers can last for more than a decade. If you calculate the processing cost per kit, a practice can see savings as soon as the second year of ownership, simply by comparing it to the cost of consumables that would have been used instead.⁴
References:
3. Exploring the Safety and Environmental Impact of Sterilization Techniques.
4. Sustainability | Reducing the Environmental Impact of Sterilization Packaging for Surgical Instruments in the Operating Room: A Comparative Life Cycle Assessment of Disposable versus Reusable Systems (mdpi.com)
Terry King BVSc MANZCVS e. terenceking70@gmail.com
C&T No.
6047
An 18-month-old female British Bulldog presented to an emergency centre with breathing difficulties encountered while exercising with her canine playmate on a warm spring afternoon (SE Queensland). She’d had one prior episode of exercise-induced overheating and respiratory difficulties that had resolved with active cooling procedures.
On presentation, she was assessed as having cyanotic mucous membranes, marked respiratory stridor, and cardiac arrhythmia; profuse salivation was noted. She required general anaesthesia and endotracheal intubation to maintain adequate oxygen saturation (SpO2 >94%). The dog was reported to have regurgitated numerous times during the evening.
Attempts to extubate her overnight were unsuccessful. She was maintained under light anaesthesia with Propofol CRI at approximately 150 µg/kg/min with the sometimes addition of Isoflurane 0.5-1.0% via a nonrebreathing circuit. The patient was transported to a referral centre the next morning, requiring propofol top-ups in transit.
On arrival, she was anaesthetised and intubated, and was markedly tachypnoeic (RR >80), hyperthermic (T 40.8° C), and tachycardic (HR 212).
Active cooling procedures were enacted, and a bolus of alfaxalone was given IV to facilitate upper airway examination and endotracheal tube replacement. Midazolam CRI (0.5mg/kg/hr) was begun, and propofol was re-instituted at 100 µg/kg/min CRI.
Abundant thick purulent mucus contents were plugging the endotracheal tube and suctioning of the upper and lower airways yielded copious amounts of purulent sputum. Subsequent chest radiographs showed an image pattern consistent with aspiration pneumonitis.
Examination of the upper airway showed typical brachycephalic anatomy (elongated soft palate with bilateral lateral saccule eversion coupled with stenotic nares) exacerbated by marked swelling and oedema of the whole oropharynx.
Once normothermia was achieved (approx. 90 minutes) and arterial blood gas analysis confirmed adequate oxygenation and ventilation with ET intubation and oxygen support (mechanical ventilation was no longer necessary), temporary tracheostomy was performed, and the oral ET tube was removed. The redundant soft palate was resected as were the lateral saccules; the lateral alar folds of each nostril had an inverted vertical-V wedge resection to provide a much larger nostril opening.
Post-operatively, the dog was supplemented with oxygen intratracheally. There was marked mucus accumulation that required clearing and suction to prevent airway obstruction. Frequent nebulising was instituted; intravenous antibiotics and gastrointestinal support drugs were begun. She was maintained on midazolam (0.5mg/kg/hr CRI) and butorphanol (0.1mg/kg/hr CRI) with propofol (6mg/kg/hr CRI) in the perioperative period.
Attempts to wean the propofol infusion were thwarted with the patient showing extreme stress with hyperventilation and rising body temperature.
Medetomidine was thus begun at 1 µg/kg/hr, midazolam and butorphanol CRI’s were continued; the propofol CRI was ceased. Within an hour, a relaxed patient with adequate arterial blood gas parameters ensued; no adverse cardiovascular changes were noted, including stable heart rate and blood pressure measurements. The medetomidine dose was reduced after 4 hours to 0.5 µg/ kg/hr and then to 0.25 µg/kg/hr after a further 4 hours. The midazolam CRI was similarly reduced (halving the infusion rate every four hours).
Twelve hours later, the dog was conscious and responsive, breathing via the tracheostomy tube without oxygen support. Sedation/analgesia now consisted of butorphanol CRI (0.05 mg/kg/hr) and medetomidine CRI (0.25 µg/kg/hr)—as the midazolam infusion had been ceased. This was maintained for a further 10 hours

before the medetomidine was able to be discontinued with the patient now comfortable, normothermic, and with normal respiration parameters.
The tracheotomy tube was removed without event on day four, her aspiration pneumonitis was resolving, she was eating and ambulatory and was discharged to her owner’s care the next day. Follow-up examination 7 and 14 days after discharge revealed a happy patient with no evident breathing problems.
The alpha-2 agonists such as medetomidine are generally not recommended for use in the critically ill because of the associated significant changes in cardiac output and blood pressure that occur, and because of the availability of other cardiovascular sparing drugs.
Although these drugs capably provide analgesia and sedation, adverse haemodynamic effects are reportedly seen even at low doses, e.g. 1 µg/kg IV, despite the effects not being as profound as regular use doses such as 10-40 µg/kg IV. Further, prolonged administration of low-dose medetomidine as CRI 1.5 µg/kg/hr has shown undesirable effects in healthy young dogs—pronounced reduction in Cardiac Index and Heart Rate, increased left atrial pressure, and reduced tissue oxygen delivery— within an hour of the infusion starting.
However, careful attention to the monitoring for adverse cardiovascular effects (e.g. HR, BP, venous PO2, lactate levels) allows us to consider the alpha-2 agonists as adjunctive agents to opioids and others to enhance analgesia and sedation in the ICU patient. For example, medetomidine (0.4 µg/kg/hr) has been shown to be an effective agent in combination with diazepam/midazolam (0.5mg/kg/hr) and fentanyl (4-9 µg/kg/hr) or morphine (0.6mg/kg/hr) in maintaining healthy dogs on mechanical ventilation via ET intubation for prolonged periods without significant measurable changes in CI, HR, MAP, lactate levels. It compared favourably, in a similar setting with the combination of Diazepam/Midazolam (0.5mg/ kg/hr) plus Fentanyl (18 µg/kg/hr) and Propofol (42 µg/ kg/min).
Opioids, sedatives, local anaesthetics, NSAIDs, NMDA receptor antagonists, and more recently anti-convulsants and anti-depressants, can all be used in various combinations to inhibit the nociceptive process at more than one site.
Combinations of sedatives and analgesics for synergism of desirable effects is not new in veterinary medicine and are often employed for enhanced analgesia, sedation,
and restraint in those ICU/critical patients experiencing or about to experience extreme pain and stress. For example, the much-acclaimed MLK mixture combines Morphine (~3.3 µg/kg/min), lignocaine (~50 µg/kg/ min) and ketamine (~10 µg/kg/min) when opioids alone have not provided acceptable analgesia and sedation. More recently, this has been superseded by the FLK combination – fentanyl (~9 µg/kg/hr) plus lignocaine (~3 mg/kg/hr) plus Ketamine (~0.6 mg/kg/hr). It allows drugs to be used in lower doses than is traditional to avoid deleterious side effects; their use potentially provides additional benefits, e.g. ketamine (in this setting) enhances analgesia while supporting BP and HR. Also, lignocaine may hinder the effects of compromised viscera, reperfusion injury, and ventricular arrhythmias due to its free-radical scavenging properties, analgesia effects, and anti-arrhythmic abilities.
The addition of micro-dose Medetomidine (0.1-1.0 µg/kg/hr) can provide the increase in sedation and analgesia needed in these critical/stressful/ painful patients. Careful monitoring should pre-empt emerging undesirable cardiovascular effects if needed for prolonged periods. As medetomidine starts to accumulate, BP will tend to rise before bradycardia occurs, allowing the astute clinician to reformulate the sedation/analgesia plan. The diuretic effect of the alpha-2 agents may be a serendipitous bonus in these patients.
Some situations where the use of medetomidine microdose CRI (0.1-1.0 µg/kg/hr) may find special use as an adjunctive agent in the critical/painful patient where it can be combined with or added to other infusions:
Continued dysphoria/anxiety/pain
Mechanical ventilation to facilitate patient-ventilator synchrony
Wind down the stressful patient, e.g.
y Tick paralysis (regurgitation and upper airway obstruction)
y Intoxications (Permethrin in Cats, Metaldehyde/ Methiocarb in Dogs)
Example 1
Medetomidine 1 µg/kg IV loading dose then CRI 0.1-1.0 µg/ kg/hr, combined with Butorphanol 0.1-0.2µg/kg/hr IV loading dose then CRI 0.1-0.2mg/kg/hr with or without Ketamine 0.5mg/kg IV loading dose then CRI 0.1mg/kg/ hr.
Example 2
Medetomidine 1 µg/kg/hr combined with Morphine 0.1mg/kg/hr or Fentanyl 1-4 µg/kg/hr and Lignocaine* 2mg/kg/hr and Ketamine 0.2mg/kg/hr.
*Lignocaine is not recommended for cats in this formula
These medications may be combined in a litre of replacement/maintenance IV fluids at a set concentration and delivered at a pre-determined rate, e.g. a 20 kg dog at so-called maintenance rates (3 mL/kg/hr = 60 mL/ hr) would have added 33.3 mg Morphine (1.1 mL of 30 mg/ mL), 666 mg Lignocaine (33.3 mL of 2% solution), 66.6 mg Ketamine (0.66 mL of 100 mg/mL) and 333 µg Medetomidine (0.33 mL of 1 mg/mL) after withdrawing a similar total volume (~35mL) of fluids from the litre bag.
The above drugs appear to be physically compatible with each other and with most IV fluids and additives. Example 2 assumes the rate of administration of the fluid largely will not change, although the rate may be increased for short periods if needed for rapid induction of analgesia and/or sedation and the rate may be reduced if sedation or other side-effects become exorbitant.
Help Wildlife Conservation & Rehabilitation w. wildscrubs.com.au
If the changing needs of one or more of the medications are forecast, an in-line syringe pump may be inserted with higher concentration/smaller volume so that the mixture can be remeasured to tailor it to the individual.
Medetomidine 1 µg/kg, Midazolam 0.5 mg/ kg, Butorphanol 0.2 mg/kg, Ketamine 1 mg/ kg with 100% oxygen supplementation
Medetomidine 1 µg/kg, Butorphanol 0.2 mg/kg, Propofol up to 1 mg /kg (to effect) with 100% oxygen supplementation
Medetomidine 1 – 4 µg/kg, Butorphanol 0.4 mg/kg, Midazolam 0.5 mg/kg with 100% oxygen supplementation
Medetomidine 1 – 4 µg/kg, Butorphanol 0.4 mg/kg, Propofol up to 1 mg/kg (to effect) intermittent slow IV boluses.
Amy—a Zoo and Wildlife Vet Nurse by trade—and her mother Sharyn established Wild Scrubs in 2019. They’ve since handmade nearly 1,700 scrub shirts, beginning with Australian wildlife print fabrics and expanding the range to include marine animals, exotic birds and mammals, and a wide range of exotic and domestic animals.
Each month, 15% of the profits is donated to a wildlife conservation or rehabilitation organisation. To date 40 different institutions—large and small—have benefitted.
The scraps from the scrub shirts are used to make scrub hats, nursing pouches, pet bandanas, scrunchies, tote bags, fluid covers, patient doughnuts, shoe covers—you name it!
Like some new gear to brighten up your day…?
Easy, send us a C&T! In 2025, winners may choose a $100 voucher to Wild Scrubs as their prize.
cve.edu.au/submit-article


Dr Moira van Dorsselaer BVSc
The Cat Clinic Hobart
150 New Town Rd
New Town TAS 7008
e. moira@catvethobart.com.au
t. +613 6227 8000
C&T No. 6048
Hotch was one of 5 kittens in a litter to a feral mother cat with defective teats, resulting in them being bottle fed from a very young age. Two of the kittens died a week apart, cause unknown. He was with a local rescue group and with 3 other young healthy kittens.
When Hotch presented to our clinic, he was 9-weeks-old, in lean body condition (3/9) but busy and considered in good health. He was vaccinated with a Felovax F3 with the plan to hold off desexing until he was in better body condition and a booster vaccination was planned for 3-4 weeks later. He had a repeat Felovax F3 vaccination 3 weeks later, was found to be in good health and in a better condition (BCS 4/9).
Four weeks later, Hotch was presented with marked lameness and a firm marked swelling of his left antebrachium. There were no obvious wounds or scabs, although he was hyperthermic. He was admitted for radiographs (see images) under sedation (dexmedetomidine 5µg/kg, methadone 0.3 mg/kg).


1
Radiographs showed signs of acute suppurative osteomyelitis, likely bacterial. This has a characteristic appearance in kittens, as the periosteum is not so strongly attached to the bone cortex, and the neutrophilic exudate lifts the periosteum, which then makes a florid new bone response ( blue arrow). Usually, these infections arise after a bite wound. The periosteal new bone formation is florid. Patchy portions of cortical bone lysis (yellow arrow) are also evident towards the centre of the lesion. At this stage we contacted Dr Richard Malik at the CVE as I had never seen anything like this before. Richard was also concerned about mild nutritional secondary hyperparathyroidism (NSH) due to the bone cortices appearing pale (osteopaenic), with an area of increased relative radiodensity immediately next to the growth plates (orange arrow). In NSH, the only normal bone is that laid down by endochondral ossification at the growth plates (and in this case—where new bone is laid down to wall off the infected bone), the rest of the skeleton is being broken down by osteoclasts under the direction of PTH.
A diet change was recommended to kitten food only, no raw meat and no meloxicam orally. He was started on oral doses of amoxicillin/clavulanate (13 mg/kg BID) and clindamycin (13 mg/kg BID) as empiric treatment for the suppurative osteomyelitis. This was chosen on the basis that the most likely bacteria were anaerobes from the oral cavity or Staphylococci from skin.
Hotch was booked in for routine castration 4 weeks later with repeat radiographs taken, which already showed improvement (see images). He continued with only oral clindamycin for a further 4 months with regular weight checkups, and dose adjustments as required. We did repeat radiographs under mild sedation a further 2 times to ensure the bone was remodeling as expected (Figure 3 ). Hotch responded almost immediately to the antibiotics and never showed signs of lameness or pain again. He was a robust, busy kitten.
Figure 1. Radiographs of the affected limb at presentation
Eventually Hotch developed diarrhoea that was unresponsive to diet changes alone. On consultation with Richard, we decided to give Hotch a ‘drug holiday’ and stop all of his antibiotics. His diarrhoea resolved within 7 days of stopping.
Final radiographs were taken 2 months later in January of this year. There were only mild boney changes present now and it was decided that Hotch as a rescue cat could be re-homed to a forever home.

2



3 4A 4B 4C


Note the generalised mild osteopaenia, with narrow lamellated cortices of many of the long bones.
Figure 3. Radiograph of the affected leg showing resolving infection and remodeling of the lesion back into a more normal skeletal appearance
Figure 4. Final radiographs showing near normal appearance of the lesion (A & B) after extensive remodelling during growth. C is the contralateral normal limb for purposes of comparison.
Liz Smit
Just Cats Tasmania
Mowbray TAS 7248
e. Liz@therbv.com
C&T No. 6049
Case 1
These radiographs are from a 9-month-old cat found by the side of the road ( Figure 1 A&B).

1A

Figure 1. Lateral (A) and DV (B) radiographs from a 9-month-old kitten suspected of having focal osteomyelitis
A. The cat had focal mid diaphyseal osteomyelitis, presumably after penetrating injury, possible after a cat bite wound
B. The cat was started on Amoxyclav (20-25 mg/kg BID), repeat radiographs were planned to monitor the cat’s progress

2A 1B 2B

2C

2. DV
and lateral (B&C) radiographs from a 9-month-old kitten suspected of having focal osteomyelitis 4 weeks after starting amoxicillin clavulanate
After 4 weeks of Amoxyclav 20-25mg/kg bid (Figure 2 A,B&C) the kitten was clinically normal and non-painful to palpate over the affected area. He was continued on a further 4 weeks of Amoxyclav.
On final recheck and radiograph he was clinically normal and antibiotics were discontinued.



Tallulah presented as an 18-week-old Domestic Short Hair kitten with a persisting left forelimb lameness. On examination, she was uncomfortable on manipulation of the forelimb and painful on palpation over the left humerus. She was quiet and played for shorter time periods. She was in good body condition and eating well but had a temperature of 39.4° C. Radiographs suggested osteomyelitis of the left humerus, with extensive moth-eaten osteolysis of the diaphysis ( Figure 4).
She was given Amoxyclav (25mg/kg BID) and re-examined and radiographed 2 weeks later—by this time she was absolutely normal, with no pain or lameness and a normal temperature.
She is currently still on her antibiotics for 8 weeks before she is reviewed for repeat X-rays and spey!

3A 3B 4A 4B 3C



Figure 5. Lateral radiograph of the affected left leg (A) compared with the normal contralateral right leg (B) 2 weeks after stating amoxicillin clavulanate. Note the irregular areas of osteolysis of the left humerus are MUCH IMPROVED.

5A 6A 6B 5B

Figure 6. Lateral radiograph of the affected left leg (A) compared with the normal contralateral right leg (B) 8 weeks after stating amoxicillin clavulanate. Note the irregular areas of osteolysis of the left humerus are MUCH IMPROVED after extensive remodelling.
Read the original article here: cve.edu.au/CnT-6035-issue-317
Dr Chloe Cheung
Resident in Small Animal Medicine
University Veterinary Teaching Hospital Sydney e. chloe.cheung@sydney.edu.au
Associate Professor Natalie Courtman
Specialist in Veterinary Clinical Pathology
Veterinary Pathology Diagnostic Services (VPDS)
Sydney School of Veterinary Science e. natalie.courtman@sydney.edu.au
t. VPDS +61 2 9351 3099
C&T No. 6050

Questions
1. Given the lack of improvement in haematocrit despite treatment with immunosuppressives, what are your other differentials?
2. What additional diagnostics would you consider at this point?
Answer Key
1. Persistent normocytic normochromic/hypochromic non-regenerative anaemia. Platelet counts were restored to normal. Possible causes of nonregenerative anaemia can be further categorised into bone marrow disorders or extramedullary causes such as chronic kidney disease or anaemia of inflammatory or endocrine diseases.
A. Bone marrow disorder
à Myelophthisis (bone marrow inflammation/necrosis, myelofibrosis, neoplasia)
The Vet Hub, Ringwood Victoria e. jiwonlee94@yahoo.com.au
Differentials
RBC parasites (e.g. Mycoplasma, Babesia, Ehrlichia, Bartonella), Neoplasia, Bone marrow disease.
Serology/PCR for the above blood parasites, imaging of full body to check for neoplasia (radiographs, ultrasound, CT scan, maybe MRI if CT scan inconclusive), bone marrow biopsy.
I would also recheck the history to see if the dog was exposed to bone marrow suppressive toxins (e.g. Oestrogen infused human medications).

compliments
à Drug-induced bone marrow disease e.g. oestrogen, phenobarbital and sulfonamides
à Myelodysplasia
à Precursor-targeted immune-mediated haemolytic anaemia
B. Chronic kidney disease anaemia is often multifactorial e.g. reduced synthesis of erythropoietin, reduced erythrocyte lifespan, chronic inflammation and in some cases mucosal ulceration and bleeding (BorinCrivellenti et al 2023)
C. Anaemia of inflammatory/chronic illness leads to iron sequestration intracellularly due to increased hepatic hepcidin production.
D. Endocrine disease
à Hyperoestrogenism
à Hypoadrenocorticism
à Hypothyroidism
2. Given the normal biochemistry and urinalysis, a lack of erythropoietin production is considered unlikely; hence, anaemia of chronic kidney disease can be excluded.
The history of chronic enteropathy may or may not be related to the anaemia. Hypocobalaminaemia / hypofolataemia has a known association with megaloblastic, non-regenerative anaemia in humans; however, the prevalence in dogs in a recent study was considered statistically insignificant (Stanley et al., 2019). Hypocobalaminaemia was present, and the patient was started on cobalamin supplementation with improved stool consistency; however, the nonregenerative anaemia persisted. Upper and lower GI scope confirmed moderate lymphoplasmacytic enterocolitis with evidence of Helicobacter spp. in the gastric mucosa with no associated mucosal changes. Hypothyroidism and hypoadrenocorticism were excluded with normal TT4 and normal pre- and postACTH stimulation cortisol.
A bone marrow aspirate/biopsy was performed and supported the diagnosis of precursor-targeted immune-mediated anaemia (PIMA), with findings of ineffective erythroid hyperplasia with minimal dysplasia and phagocytosis of late-stage erythrocyte precursors particularly metarubricytes.
The patient was subsequently treated with an increased dose of corticosteroids at 2.5 mg/kg/day and the addition of leflunomide at 2 mg/kg q24h. His PCV increased from 0.22 L/L to 0.30 L/L with signs of macrocytosis and hypochromia after 2 weeks

of the new treatment, supporting the diagnosis of PIMA. Prednisolone was continued to be tapered at 25% dose reduction every 4-6 weeks as the patient and the PCV continued to be stable. At the time of writing, the patient continued to be in clinical remission and prednisolone was completely ceased and maintained on sole therapy of leflunomide with the plan of gradual dose tapering in 3 months.
PIMA is defined as persistent non-regenerative anaemia with bone marrow evidence of ineffective erythropoiesis, minimal dysplasia and phagocytosis of erythrocyte precursors (Lucidi et al., 2017). On the exclusion of other causes of chronic anaemia, any non-regenerative anaemia of over 5 days duration should raise the suspicion of PIMA and bone marrow evaluation considered. Severe anaemia (with a median haematocrit of 13%) is often documented, with the most common presenting complaint of lethargy (Assenmacher et al., 2019). The disease pathogenesis is presumed to be immune targeting and destruction of erythroid precursors, based on positive clinical response towards immunosuppressants and reports of relapse on cessation of immunosuppressant (Lucidi et al., 2017).
An immune-mediated mechanism for the anaemia was suggested by the positive saline agglutination test performed by the referring Veterinarian; however, the negative Coombs test did not support this. The discrepancy between these tests reflects a false positive saline agglutination test or a false negative Coombs test. False positive saline agglutination test can occur if a low saline dilution is used e.g. 1:2 rather than 1:5, especially if there is hyperglobulinaemia as persistent rouleaux can be confused with agglutination. It can also be harder to assess if RBC are truly agglutinating if the RBC density on the agglutination prep is too high (because of lack of dilution)—bumping the coverslip to watch the cells tumble around to see if they stay attached to each other or drift apart can assist with evaluation.
False negative Coombs tests can occur if the Coombs reagent is not polyvalent e.g. is only for IgG/IgM but not complement, if large amounts of Ab are present (causes prozone effect) which can be detected by running with further dilution, if testing is delayed as this may lead to detachment of Ab or complement (can also cause false positives due to complement binding) or if there is elution of weakly bound Ab with RBC washing step. The newer antiglobulin gel test is more sensitive than the original DAT test which may be partially because it reduces or avoids the elution of weak Ab issue.
Glucocorticoids are recommended as the first line of treatment at a median dosage of 2 mg/kg/day and many cases also require adjunctive immunosuppressants, e.g. azathioprine, cyclosporine, and mycophenolate, (Assenmacher et al., 2019). Median time for response to therapy has been reported as 29 days, with some dogs taking over 3 months (Assenmacher et al., 2019). There is a lack of literature evidence on the use of specific immunosuppressants for the management of PIMA. Leflunomide, a selective inhibitor of de novo pyrimidine synthesis, was selected in this case based on anecdotal and literature evidence of positive clinical responses in other immune-mediated conditions e.g. immunemediated haemolytic anaemia, immune-mediated thrombocytopenia, immune-mediated polyarthritis, etc., with higher incidence of adverse effects, mainly gastrointestinal signs, at doses higher than 4 mg/kg/ day (Breedveld & Dayer, 2000; Chesne et al., 2024). Cyclosporine and mycophenolate are the most reported adjunctive immunosuppressants, both with prolonged durations to reach treatment response, hence treatment should be continued for at least 2 months, prior to deeming it non-responsive (Sugawara-Suda et al., 2023).
References
Assenmacher, T.D., Jutkowitz, L.A., Koenigshof, A.M., de A Lucidi, C., Scott, M. A. (2019) ‘Clinical features of precursor-targeted immunemediated anemia in dogs: 66 cases (2004-2013)’, Journal of the American Veterinary Medical Association 255(3), pp. 366–376.
Breedveld, F., Dayer, J. (2000) ‘Leflunomide: mode of action in the treatment of rheumatoid arthritis’, Annals of the Rheumatic Diseases, 59(11), pp. 841-849.
Chesne, R.B., Doornink, M.T., Sri-Jayantha, L.S., Urie, B.K. (2024) ‘Leflunomide with prednisone or non-steroidal anti-inflammatory drug therapy is safe and tolerated for long-term treatment of immunemediated polyarthritis in 27 dogs’, Journal of the American Veterinary Medical Association, 262(9), pp. 1188-1192.
Lucidi, C.A., de Rezende, C.L.E., Jutkowitz, L.A., Scott, M.A. (2017) ‘Histologic and cytologic bone marrow findings in dogs with suspected precursor-targeted immune-mediated anaemia and associated phagocytosis of erythroid precursors’, Veterinary Clinical Pathology, 46, pp. 401-415.
Stanley, E., Appleman, E., Schlag, A., Siegel, A. (2019) ‘Relationship between cobalamin and folate deficiencies and anemia in dogs’, Journal of Veterinary Internal Medicine, 33(1), pp. 106-113.
Borin-Crivellenti, S., Crivellenti, L. Z., Gilor, C., Gilor, S., Silva, D. G., Maia, S. R., Costa, P. B., Alvarenga, A. W. O., Fernandes, A. L. S., & Santana, A. E. (2023). Anemia in canine chronic kidney disease is multifactorial and associated with decreased erythroid precursor cells, gastrointestinal bleeding, and systemic inflammation. American journal of veterinary research 84(10), 1–6.
Sugawara-Suda, M., Morishita, K., Iwanaga, Y., Yamazaki, J., Kagawa, Y, Yokoyama, N., Sasaki, N., Ohta, H., Nakamura, K., Takiguchi. (2023) ‘Investigation of the therapeutic effects, predictors, and complications of long-term immunosuppressive therapy in dogs with precursortargeted immune-mediated anemia’, The Journal of Veterinary Medical Science, 85(7), pp. 695-701.
Jessica Searle
Veterinary Surgeon Border Veterinary Clinic
e. jessica.searle@apiam.com.au
C&T No. 6051
I was just wanting to share a small thing I recently discovered with other vets in the hope it will help others out.
Basset Hound legs are very difficult to get IV catheters into due to the combination of chondrodystrophy and excess skin.
They do however have excellent ear veins that are very easy to place a catheter into, so if you can’t find a leg vein then try clipping the edge of an ear.

Image source reddit.com/r/Veterinary/comments/ zqp33q/ear_veins_are_always_an_option/?rdt=57470

Video source tiktok.com/@monikki1/ video/7080229056695799086
Madeleine Roberts BVSc (Hons 1) FANZCVS Small Animal Medicine Registered Specialist in Small Animal Medicine
e. Madeleine.Roberts@glasgow.ac.uk
Shannon Donahoe DVM PhD Dipl. ACVP
Registered
Specialist in Veterinary Anatomical Pathology
The University of Sydney
C&T No. 6052
Two ten-week-old American Staffordshire Bull Terrier littermates presented for progressive hind limb weakness of approximately two weeks’ duration. The dogs had reportedly been fed a commercial puppy diet and had received a single live-attenuated C3 vaccination one week prior to presentation. During hospitalisation the dogs developed progressive paraparesis, mentation changes, coughing and trismus. One puppy developed neurological deficits consistent with a right forebrain lesion. Clinical examination, serum biochemistry results and Neospora caninum serology was consistent with neosporosis. Both puppies were humanely euthanised due to rapid deterioration and guarded clinical prognosis. Histopathology indicated intramuscular protozoal zoites, consistent with a protozoal polymyopathy.
The patient presented for hind limb lameness and intermittent diarrhoea. The puppy was reported to have been previously well and eating a commercial puppy diet. The patient had recently been seen by their attending veterinarian for similar clinical signs and was commenced on fenbendazole (50mg/kg PO, currently on day 2 of 5) and probiotics. On initial physical examination the puppy was bright and alert. Vitals signs were within reference ranges. While small, the puppy was in normal body condition (4/9). The right hind limb was hyperextended and unable to be flexed ( Figure 1). There was reduced paw placement in both hind limbs. Cranial nerve examination was normal. No muscle or long bone pain was identified. Pelvic limb radiographs did not identify any orthopaedic abnormality as a cause of the patients’ clinical signs. The patient was discharged into the owners’ care with the view to be reassessed the following day at their primary veterinarian.
Two days later the patient represented and was noted to be quiet with paraparesis and hyperextension of both hind limbs. Conscious proprioception was delayed

in both hind limbs, with the right worse than the left. Spinal reflexes were absent. Vital signs remained within reference limits.
Haematology and biochemistry were performed (Table 1). Changes were suggestive of muscular injury (CK 3744 U/L {RR 51–223 U/L}, ALT 217 U/L {RR 10–95}) along with an inflammatory focus (C-reactive protein 49.6 mg/L {RR <10 mg/L}). Other abnormalities including the mild increases in ALP, a mild total hypercalcaemia and mild hyperphosphataemia most likely reflected age-related change.
Given the quiet demeanour of the puppy, a resting ammonia was obtained and was mildly increased 130 µmol/l (RR 0–99 µmol/l). A bile acid stimulation test was subsequently performed which was normal (prestimulation 3 µmol/l, post 5 µmol/l {RR <21 µmol/l}), suggesting the hyperammonaemia was a spurious result. A faecal analysis (to evaluate for infectious causes of diarrhoea) was not performed due to financial limitations.
Based on the presenting signs, clinical examination findings and initial biochemistry results, a neuromuscular disease was considered a leading diagnostic possibility. An infectious disease such as neosporosis or toxoplasmosis was strongly suspected based on the age of the patient and progressive physical changes. Other possible causes for the neuromuscular signs that were considered included, muscular dystrophies, neural angiostrongylosis (NA), canine distemper virus (CDV), tetanus, or congenital myotonia. The hyperammonemia was most likely spurious, given the normal bile acid stimulation test. In-house ammonia assessments are very labile with very specific handling techniques, and when increased should always be complemented with additional hepatic function testing (such as a bile acid stimulation test).
Table 1. Haematology results for Case 1 on second presentation

The patient was treated with buprenorphine 0.02mg/ kg intravenously in addition to intravenous fluid therapy (Hartmann’s solution). Over the course of the next 2 days the patient rapidly deteriorated and was non ambulatory with absent spinal reflexes, minimal voluntary motor control and moderate to severe muscle contracture in hind limbs. The patient had newly identified trismus and sardonic grin ( Image 2 and 3 ).
Contact with the owner was lost following readmission. Empirical treatment with trimethoprim sulphonamide (15mg/kg IV) was commenced while Neospora caninum and Toxoplasma gondii serology titres were pending. Due to the deterioration, concerns over patient welfare and guarded prognosis, the patient was humanely euthanised. The body was submitted for postmortem evaluation.
A male entire litter mate was presented to the emergency department for concerns of a seizure-like event at home and general weakness. The patient was a litter mate of Case 1 and had been in the possession of a new owner for the past week. The patient was eating a commercial dry food diet. On physical examination the patient was quiet

and lethargic. The patient was poorly ambulatory with profound hind limb weakness and muscle contraction. Masticatory muscle atrophy was noted with associated trismus. Due to financial limitations and a similar presentation to the littermate, serological evaluations for T. gondii and N. caninum were submitted. Supportive care with intravenous fluid therapy, buprenorphine
analgesia (0.02mg/kg IV) and trimethoprim sulphonamide (15mg/kg IV) was commenced.
Over the next 2 days, signs of progressive central nervous system involvement became apparent including a left sided head tilt, reduced menace response in the right and reduced facial sensation along the right nasal mucosa. In addition to these changes, the patient developed a fever, cough and increased bronchovesicular sounds on the right, raising concern for pneumonia. Contact with both the owner and breeder were lost immediately following admission. Due to the marked deterioration and concern for newly developed pneumonia, the patient was humanely euthanised on welfare grounds.
Toxoplasma gondii and N. caninum serology (IFA) for both patients returned on the final day of hospitalisation. Both cases returned with a positive N. caninum IgG (end titre > 1:1,024) and negative T. gondii IgG and IgM (end titres <1:16 for both).
A port-mortem examination was performed on both patients. Gross morphological changes in both patients indicated diffuse muscle atrophy, worse in the hindlimbs, lymphadenomegaly and moderate pulmonary oedema. Case B had additional changes of meningeal congestion in the right hemisphere.
Microscopy of Case 1 confirmed polymyositis, polyradiculoneuritis, myocarditis and encephalomyelitis with intralesional protozoal zoites. Intralesional protozoal zoites were identified with the ileum muscularis and oesophagus but not elsewhere within the gastrointestinal tract. There was no evidence of pulmonary interstitial or alveolar protozoal infiltrates. Microscopy of Case 2 tissue was similar except for an absence of oesophageal muscularis lesions.
Neospora caninum is an obligate intracellular cystforming protozoal parasite. The parasite has an indirect lifecycle with canines as the definitive host and intermediate hosts including cattle and sheep. There are 3 infectious life stages including sporozoites (within sporulated oocysts), rapidly dividing tachyzoites and slowly proliferating bradyzoites within tissue cysts (Donahoe et al 2015). Dogs can become infected via horizontal transmission involving the ingestion of tissue containing zoites or through ingestion of food/water containing sporulated oocysts. Vertical transmission, from an infected dam to offspring, can occur by both transplacental and transmammary routes (Silva and Machado 2016). In this case, transplacental transmission was considered most likely as there was not a known

history of consumption of raw meat and due to the age of the puppies at time of presentation.
Neosporosis is associated with a range of clinical syndromes including polymyositis, multifocal central nervous system disease, dermatitis, hepatitis and pneumonia. Congenitally infected puppies, as suspected in these cases, present with ascending paralysis with hyperextension of the hindlimbs due to the predilection of N. caninum for lumbosacral spinal nerve roots. Clinical signs usually become apparent between 5 weeks to 6-months-of-age. Arthrogryposis, permanent rigid contracture of muscle, results from the formation of scar tissue in affected muscles.
A presumptive diagnosis of neosporosis is made by suggestive clinical signs, serological testing and eliminating other possible causes of disease. While at low titre levels there can be serological cross reactivity with T. gondii, minimal cross reactivity is reported to occur at high titres when measured by indirect fluorescent antibody testing (Silva and Machado 2016). It is pertinent to acknowledge that negative titre results can also occur in acute infections as antibody levels usually take 2 to 3 weeks from infection to be detectable. The gold standard of identification is detection of tachyzoites on cytology/ histopathology or through polymerase chain reaction testing. Ante-mortem samples that could have been obtained in these cases include muscle biopsy or CSF cytology.
Treatment of neosporosis is challenging, with the goal often being to control clinical manifestations as opposed to parasitological cure. Inactive bradyzoite cysts can persist in tissue and become reactivated during periods
This scholarship is valued at AU$8,000 to be used toward enrolment into any CVE continuing education course(s) commencing in the year the scholarship is awarded.
Established specifically to recognise and reward loyal CVE members, it commences in 2025—our 60th anniversary year—and applications were open to members who have maintained continuous membership for the last three consecutive years at the point of application.
It aims to assist a qualified veterinarian and loyal CVE Member to enhance their professional skills
of immunological stress. Treatment options often include clindamycin with or without concurrent trimethoprimsulfonamide or pyrimethamine-sulfonamide for prolonged periods (months). As would be expected, once progressive disease has been identified treatment responses are poor. It is extremely unlikely either of the cases presented here would have demonstrated a favourable response to treatment before succumbing to complications of their disease.
An added complexity for these cases was the loss of communication with their respective owners following admission to the hospital. We can only postulate the reasons as to why this occurred. This placed the clinical team in a challenging position as no consent for ongoing treatment had been obtained nor had a clear reassessment been provided to the owners as the patients continued to deteriorate. Both were considered abandoned when no communication pathways were able to be forged after a 48-hour period. A decision to humanely euthanize both patients was made in accordance with the Prevention of Cruelty to Animals Act 1979 – Section 26AA. Veterinarians are encouraged to review these guidelines and communicate with clients and/or staff members in these clinical scenarios.
Donahoe, S. L., Lindsay, S. A., Krockenberger, M., Phalen, D., & Šlapeta, J. (2015). A review of neosporosis and pathologic findings of Neospora caninum infection in wildlife. International journal for parasitology Parasites and wildlife, 4(2), 216 - 238. doi.org/10.1016/j. ijppaw.2015.04.002
Silva, R. C., & Machado, G., P. (2016) Canine neosporosis: perspectives on pathogenesis and management. Veterinary Medicine: Research and Reports, 7, 59 – 70. doi.org/10.2147/VMRR.S76969

through continuing veterinary education and practical professional development.
Applications for the 2025 scholarship closed 30 November 2024.
The recipient of this inaugural scholarship will be announced early 2025 through all CVE channels.
Thank you for choosing to be a CVE member.
17 - 19 February 2025 | Webster Lecture Theatre
Veterinary Science Conference Centre, Sydney

3 days for $1,140 for CVE members – best value in 2025!

Andrea Harvey BVSc PhD DSAM (Feline)
DipECVIMCA MRCVS MANZCVS (Animal Welfare)
Specialist in Small Animal and Feline Medicine
I’m enormously excited about having Sam Taylor from the UK join me as a key note speaker at this conference. Sam is one of the world's leading lights of feline medicine and a highly sought after engaging speaker whose love of cats shines through in everything that she does. I’m honoured to have been Sam’s residency mentor where we both trained at the world renowned Feline Centre at the University of Bristol and we’ve done so much work together previously from clinical cases, spearheading the Cat Friendly Clinic scheme, writing textbooks and so much more.
We’ve now had 14 years on opposite sides of the world getting different experiences but our early background together has given us a shared philosophy in taking a

very holistic approach to the cat and we wanted this to be uniquely reflected in the conference by way of incorporating ethics, welfare, behaviour, environment, nutrition and client factors into case management. Veterinary medicine has advanced so much but I feel that we can still do so much better in managing chronic diseases in our feline patients by taking this holistic approach, and this is why I wanted to dedicate a whole conference to this.
This is a unique opportunity to have Sam Taylor and I in the same country let alone the same conference! We are joined by a wide range of local experts that I have personally hand picked from across Sydney as veterinarians that I have the greatest respect and admiration for in their care for cats. Join us for his unique feline event to learn more about how to provide the best care for our cats with chronic diseases and to have fun together whilst doing so!
Program Highlights
Comprehensive Coverage of Chronic Conditions:
y Managing gastrointestinal diseases (IBD and diffuse small cell lymphoma) and inflammatory liver conditions.
y Treating feline osteoarthritis and diabetes.

Chronic diseases are among the most common and complex conditions encountered in feline practice, especially in older cats. These conditions significantly affect quality of life and require a nuanced understanding of multiple comorbidity, clinical management, and practical treatment strategies.
THIS IS THE ART AS WELL AS THE SCIENCE OF FELINE MEDICINE.
This conference provides insights into cutting-edge therapies and approaches for managing conditions like chronic kidney disease, hyperthyroidism, gastrointestinal disorders, and feline idiopathic cystitis. It also touches upon some new important syndromes like acromegaly and feline eosinophilic sclerosing fibroplasia, gives pertinent updates about clinical pathology, and includes exciting new developments in feline pharmacology and therapeutics, like the SGLT2 inhibitors for managing diabetes.
Whether you’re an experienced veterinarian, a recent graduate, or a DVM student, this event offers practical tools to enhance your ability to understand care for feline patients.
This conference is designed to deliver exceptional value by balancing affordability with top-tier content. Chronic diseases in cats are often under-discussed, yet they pose significant challenges for veterinarians worldwide.

y Updates on managing chronic kidney disease and hyperthyroidism in older cats.
y Idiopathic Cystitis
Practical Focus:
y ‘Top Tips’ for managing acutely presenting chronic diseases.
y Case studies
Cutting-Edge Insights:
y The latest research on feline eosinophilic sclerosing fibroplasia and acromegaly.
y Updates on FIP management and research breakthroughs.
Plenary Talks:
y Ethical considerations
y Insights into chronic diseases in koalas and how they relate to cats.
Understanding these conditions’ nuances and learning how to optimize treatment plans can greatly improve outcomes for your feline patients.
Key Benefits Include:
Gaining actionable knowledge from internationally renowned feline experts, including Dr. Andrea Harvey, Dr. Samantha Taylor, Michael Linton and Randolph Baral Participating in interactive panel discussions that foster deeper understanding and problem-solving. Enhancing your clinical skills with the latest evidence-based practices.
To make this event as inclusive as possible, we’ve structured our pricing to be significantly lower than other conferences of this calibre. Early bird rates for CVE members start at $1,140, with special discounts for recent graduates and students.
"The goal is simple: ensure as many veterinarians as possible can access this transformative educational opportunity.
–Richard Malik
BVSc MRCVS MANZCVS (feline) PGDip PhD
C&T No. 6053



Nathalie graduated from Massey University, New Zealand in 2002 and became a member of the ANZCVSc in Feline Medicine in 2012. Nathalie is an RCVS Advanced Practitioner in Feline Medicine, holds a diploma in international animal welfare ethics and law from Edinburgh University, and a PhD in feline ageing from the University of Liverpool. Nathalie established the Feline Healthy Ageing Clinic in association with Royal Canin and continues working parttime as a post doctoral researcher for the clinic, in addition to being head of the International Society of Feline Medicine (ISFM).
Pain is a complex experience that involves the sensorial system but also has an emotional component. It is therefore important to understand and recognise the types of pain and their management, as well as the factors that influence the individual experience of pain and the emotions involved.
The official definition of pain from the International Association for the Study of Pain (IASP) states it is ‘an unpleasant sensory and emotional experience associated with, or resembling that associated with, actual or potential tissue damage’. Physiological (adaptive) pain, the stimulation of the nociceptive sensory system by a noxious substance and the transmission of this message to higher centres is essentially a protective function.1 However, the individual experience of pain is also influenced by additional factors; current emotional state, past experiences, cognitive ability and the environment they are in at the time pain is experienced all contribute to what is perceived by the individual.1 In the veterinary field, these additional factors are important for us to understand as we can try to influence the environment and the emotional state of our patients as part of our pain management protocols. Additionally, through these actions, we will hopefully create a cognitive experience for our patients that prevents the learning of ‘negative experiences’ which may impact future pain management.
The 2022 WSAVA Guidelines set out the differences between adaptive/acute/ physiological pain and chronic/maladaptive pain.¹ In summary, adaptive/acute/ physiological pain serves a protective purpose; however, in the case of interventional procedures such as surgery, this protective function is not needed so we must act to negate this purpose. Chronic/maladaptive pain serves no biological purpose, it persists beyond the expected course of acute stimulation and is not associated with healing; it has no clear endpoint.
For more detailed discussion on types of pain, please see the 2022 WSAVA guidelines (wsava.org/global-guidelines/ pain-guidelines/) for the recognition, assessment and treatment of pain.¹
The emotional state of the cat has a significant impact on their pain perception. Fear–anxiety can exacerbate pain and pain can exacerbate fear–anxiety ( Figure 1).2,3 Ensuring we are working in a manner that reduces fear–anxiety in our feline patients is important not just to reduce the perception of pain in the individual, but also the cognitive experience. If an individual perceives an injection in the veterinary clinic as being painful, they will learn from the experience and the next time this occurs, they may respond with behaviours that risk injury to staff members. In addition, this memory of the previous pain experience may further increase the perception of pain when the next injection is given! Ensuring that we are creating a physical and social environment in our clinics

that supports the cat as a cognitive and emotional being is part of a pain management strategy for the clinic and will be discussed later as part of the strategy for chronic pain management in the home.
For further information on creating a supportive experience for your feline patients, please see the 2022 ISFM/AAFP cat friendly guidelines (wsava.org/ global-guidelines/pain-guidelines/).4,5
While it may be easy to recognise and understand the relationship between acute pain and protective behaviours in the cat, such as trying to escape or striking/biting when they cannot achieve this, the longstanding nature of chronic pain and the long-term effect that this has on the cat's emotional health and behaviour
can be more individual and gradual. The behaviour changes seen may be a result of the cats adapting normal behaviours in the face of chronic pain to continue to try and meet their behaviour needs; they may express as ‘problem’ behaviours or changes to the cat’s emotional state or a combination of all of these. Chronic pain increases the likelihood of the cat existing with a protective emotional bias and showing more avoidance or repelling behaviours within their social environment.
Detailed discussion on recognition of acute pain is outside the scope of this article but further information can be found in the 2022 ISFM consensus guidelines on the management of acute pain in cats.⁶
The recognition and diagnosis of chronic pain starts with either the diagnosis of a condition that is known to be painful (e.g. osteoarthritis, cancer or dental disease), the identification of persistent pain post-surgical intervention or from the presentation of a cat with clinical signs (including changes in behaviour) that raise the suspicion that chronic pain may be an underlying cause ( Figure 2).
The sensory component of chronic pain is mostly assessed by clinical examination and manipulation. This is


essentially a subjective measure and will depend on the force used in the manipulation and our interpretation of the response7 Imaging can also be used in some conditions to help support the diagnosis but abnormal findings may not always be painful and painful conditions may not have detectable changes.
The observed behavioural change associated with chronic pain is dependent on the location and type of chronic pain being experienced. Decreased activity levels, decreased ability to perform activities, changes in appetite, changes in toileting habits, unkempt haircoat and claws, alopecia, skin rippling, decreased socialisation, general loss of interest and sudden episodes of vocalisation or agitation are the common changes associated with chronic pain.7
The affective and cognitive components of chronic pain are generally assessed using pain scoring systems that assess the motivational and emotional consequences, in addition to adaption (learning) of the chronic pain and how this impacts the cat’s behaviour. To date, validated tools for chronic pain are predominantly limited to those developed for detecting and monitoring feline osteoarthritis (OA). Of these, the Feline Musculoskeletal Pain Index has gone through the most validation.8–13
‘Client-Specific Outcome Measures’ is a tool that is more specific to the individual animal14–16 and is based on distinct activities that the owner feels are problematic to their cat.
Additionally, there is also the ‘Montreal Instrument for Cat Arthritis Testing’ which was originally validated for veterinarians17,18 but also has a version for owners.19 These tools are helpful in the diagnosis of chronic pain associated with feline OA but are also used in monitoring the response to treatment. Outside of feline OA, health-related qualityof-life tools can also be used to assess the impact that chronic pain is having on the cat’s welfare.7 A number of these tools are available and have validation studies published.20 For general use outside of specific diseases, the Cat Health and Wellbeing (CHEW) questionnaire18 and the web-based VetMetrica tool19-21 are the most well known. The CHEW questionnaire is available in the supplementary material for use (see Freeman et al21) and VetMetrica can be accessed via a clinic subscription, details of which can be found on their website: newmetrica.com/vetmet rica-hrql/.
While analgesia is central to chronic pain management, additional tools can also be used. Where possible, response to analgesia should be monitored using one of the chronic pain assessment tools but it is important to remember that no response does not mean that chronic pain was not present or has not been reduced. There may be several different types of pain present and multimodal combination of therapies, including the use of adjunctive drugs, may need to be used.

Figure 3. Ensure there is easy access to resources such as places to rest and hide.
Image courtesy Laura Watson
In addition, the social and physical environment the cat is living in needs to be looked at and discussion had to ensure this is adapted to meet the cat’s changing physical and emotional needs. This includes, for example, ensuring easy access to food, water and toileting areas, as well as places to rest and hide where they are not having to jump or climb and can access easily without having to have social contact with other cats, pets or people in the house ( Figure 3).
Weight loss may be advised in cases of OA to reduce the mechanical load on the joints or changes in food texture may be suggested for cats with dental pain. Feline pheromone use can help to create ‘safe’ places in the home environment for the cat and advice may need to be given to the owner, encouraging them to change how they physically interact with their cat. The type of adaptation needed is individual to the cat and the environment they are living in.
Physical rehabilitation can aid cats with musculoskeletal conditions or neurological impairment and other modalities such as cold therapy, heat therapy, cannabinoids, dietary supplements, acupuncture and physical therapy or massage may be useful in some individuals. However, these should not be prioritised over appropriate analgesia and environmental management.
1. Monteiro BP, Lascelles BDX, Murrell J, et al. 2022 WSAVA guidelines for the recognition, assessment and treatment of pain. J Small Anim Pract 2023; 64: 177–254.
2. Heath S. Environment and feline health: at home and in the clinic. Vet Clin North Am Small Anim Pract 2020; 50: 663–693.
3. Panksepp J. Affective neuroscience: the foundations of human and animal emotions. Oxford University Press, 1998.
4. Rodan I, Dowgray N, Carney HC, et al. 2022 AAFP/ISFM cat friendly veterinary interaction guidelines: approach and handling techniques. J Feline Med Surg 2022; 24: 1093–1132.
5. Taylor S, St Denis K, Collins S, et al. 2022 ISFM/AAFP cat friendly veterinary environment guidelines. J Feline Med Surg 2022; 24: 1133–1163.
6. Steagall PV, Robertson S, Simon B, et al. 2022 ISFM consensus guidelines on the management of acute pain in cats. J Feline Med Surg 2022; 24: 4–30.
7. Monteiro BP and Steagall PV. Chronic pain in cats: recent advances in clinical assessment. J Feline Med Surg 2019; 21: 601–614.

8. Benito J, Gruen ME, Thomson A, et al. Owner- assessed indices of quality of life in cats and the relationship to the presence of degenerative joint disease. J Feline Med Surg 2012; 14: 863–870.
9. Benito J, DePuy V, Hardie E, et al. Reliability and discriminatory testing of a client-based metrology instrument, feline musculoskeletal pain index (FMPI) for the evaluation of degenerative joint disease-associated pain in cats . Vet J 2013; 196: 368–373.
10. Benito J, Hansen B, Depuy V, et al. Feline Musculoskeletal Pain Index: responsiveness and testing of criterion validity. J Vet Intern Med 2013; 27: 474–482.
11. Zamprogno H, Hansen BD, Bondell HD, et al. Item generation and design testing of a questionnaire to assess degenerative joint disease-associated pain in cats. Am J Vet Res 2010; 71: 1417–1424.
12. Enomoto M, Lascelles BDX and Gruen ME Development of a checklist for the detection of degenerative joint diseaseassociated pain in cats . J Feline Med Surg 2020; 22: 1137–1147.
13. Enomoto M, Lascelles BDX, Robertson JB, et al. Refinement of the Feline Musculoskeletal Pain Index (FMPI) and development of the short- form FMPI. J Feline Med Surg 2022; 24: 142–151.
14. Gruen ME, Griffith EH, Thomson AE, et al. Criterion validation testing of clinical metrology instruments for measuring degenerative joint disease associated mobility impairment in cats. PLoS One 2015; 10. DOI: 10.1371/journal.pone.0131839
15. Gruen ME, Thomson AE, Griffith EH, et al. A feline-specific antinerve growth factor antibody improves mobility in cats with degenerative joint disease–associated pain: a pilot proof of concept study. J Vet Intern Med 2016; 30: 1138–1148.
16. Lascelles BDX, Hansen BD, Roe S, et al. Evaluation of clientspecific outcome measures and activity monitoring to measure pain relief in cats with osteoarthritis. J Vet Emerg Crit Care 2007; 21: 410–416.
17. Klinck MP, Rialland P, Guillot M, et al. Preliminary validation and reliability testing of the montreal instrument for cat arthritis testing, for use by veterinarians, in a colony of laboratory cats Anim 2015; 5: 1252–1267.
18. Klinck MP, Monteiro BP, Lussier B, et al. Refinement of the Montreal Instrument for Cat Arthritis Testing, for use by veterinarians: detection of naturally occurring osteoarthritis in laboratory cats. J Feline Med Surg 2018; 20: 728–740.
19. Klinck MP, Gruen ME, del Castillo JRE, et al. Development and preliminary validity and reliability of the Montreal Instrument for Cat Arthritis Testing, for use by caretaker/owner, MI-CAT(C), via a randomised clinical trial. Appl Anim Behav Sci 2018; 200: 96–105.
20. Doit H, Dean RS, Duz M, et al. A systematic review of the quality of life assessment tools for cats in the published literature. Vet J 2021;22. DOI: 10.1016/j.tvjl.2021.105658.
21. Freeman LM, Rodenberg C, Narayanan A, et al. Development and initial validation of the Cat HEalth and Wellbeing (CHEW) questionnaire: a generic health-related quality of life instrument for cats. J Feline Med Surg 2016; 18: 689–701.
22. Noble CE, Wiseman-Orr LM, Scott ME, et al. Development, initial validation and reliability testing of a web-based, generic feline health- related quality-of-life instrument. J Feline Med Surg 2019; 21: 84–94.
23. Scott EM, Davies V, Nolan AM, et al. Validity and responsiveness of the generic health- related quality of life instrument (VetMetrica™) in cats with osteoarthritis. Comparison of vet and owner impressions of quality of life impact Front Vet Sci 2021; 8. DOI: 10.3389/fvets.2021.733812
24. Davies V, Reid J and Scott EM. Optimisation of scores generated by an online feline health–related quality of life (HRQL) instrument to assist the veterinary user interpret its results Front Vet Sci 2021; 7. DOI: 10.3389/fvets.2020.601304.

Welcome to Research Roundup where we bring you summaries of the latest feline research including a selection of different articles on a variety of topics, with an emphasis on analgesia and anaesthesia. In this month's roundup, we examine the effect of surgeon experience on pain and wound healing, training to perform pain scoring, caregiver abilities to identify pain behaviours and anaesthetic complications.

Read here: cve.edu.au/rr-dec-24
The International Society of Feline Medicine is the veterinary division of the pioneering cat welfare charity International Cat Care. Trusted by vets and nurses, it provides a worldwide resource on feline health and wellbeing, via the Journal of Feline Medicine of Surgery, by fostering an international community of veterinary professionals with a shared vision of feline welfare, and supporting professional development with practical CPD. Additionally, International Cat Care’s website provides a valuable resource of accurate information delivering what both vets and cats would want owners to know … having done this course have changed my way of
-Mireia Balliu Cristina, Spain, 2021 Participant


Dr Victoria Ludlow
Associate Veterinarian
Willunga & Aldinga Veterinary Services
e. tludlow@willungavets.com.au
Dr Jeremy Rogers
Senior Veterinary Officer
Department of Primary Industries and Regions, South Australia (PIRSA)
Murray Bridge SA
e. Jeremy.Rogers@sa.gov.au
C&T No. 6054
Introduction
In November 2023, a private veterinarian was called to a property on the Fleurieu Peninsula to inspect a steer with unusual skin lesions, predominantly on the left side. The raised lesions were unusual in appearance and considering lumpy skin disease (LSD) as a potential diagnosis, the case was reported to PIRSA. Samples were collected for analysis. LSD was ruled out and a diagnosis of Actinobacillus dermatitis was made. The cutaneous form of Actinobacillus has rarely been reported in Australian cattle.
The 12-month-old speckle park steer was born on the property. Skin lesions were noticed about 2 weeks prior to the vet visit and had been slowly increasing in size. The lesions were at multiple sites on the body, but mainly the left side. The steer mixed with a number of other cattle on the property; however, no other animals were showing signs. The cattle had not been injected recently and there had been no new arrivals onto the property. The owner had treated the lesions with topical antibacterial wound spray.
The lumps were raised and somewhat circular in appearance. The predominant lesion was located just cranial to the left forelimb shoulder, in the pre-scapular region. It measured approximately 10 cm x 15 cm x 3 cm.It was multi-lobulated and had a crusted, hairless surface (Figure 1a). A similar but smaller lesion measuring approximately 5 cm was present on the caudal abdomen,


just cranial to the left hindlimb thigh, in the pre-femoral region (Figure 1b). A few less obvious lesions were also present on the medial aspect of the left hindlimb thigh.
When pressure was applied, a cream-coloured, thick exudate was discharged from the pre-scapular lesion ( Figure 2). After removing the external crust, the lesions had a granulomatous appearance. The underlying tissue was dense and haemorrhagic (Figure 3)

Figure 3. Pre-scapular lesion once scab was removed. Underlying tissue had a granulomatous appearance and was very haemorrhagic.
All other physical exam parameters were considered normal.
A number of conditions were considered as differentials including ulcerative lymphangitis, Actinobacillus, Actinomycosis, cutaneous lymphoma and lumpy skin disease. Incisional biopsies were collected and sent for analysis.
The steer was treated with a long-acting, intramuscular antibiotic injection (oxytetracycline), a subcutaneous anti-inflammatory injection (meloxicam) and intravenous sodium iodine at a dose of 66 mg/kg.
A second dose of sodium iodine was repeated 2 weeks later. Images were taken following the first (Figure 4) and 6 weeks after the second (Figure 5) sodium iodide treatment. There was an obvious reduction in size of the lesions following the first dose. The prescapular lesion measured approximately 6 cm x 4 cm x 1 cm and appeared a lot less inflamed. The prefemoral lesion was no longer raised and the area had contracted down significantly. Six weeks after the second treatment, the prescapular lesion has further reduced in size to approximately 3 cm x 1.5 cm x 1cm and the prefemoral lesion had completely resolved.
Genetic testing for LSD was performed at the Australian Centre for Disease Preparedness. Lumpy skin disease

Figure 4. Prescapular (a) and prefemoral (b) lesions following treatment with intravenous sodium iodide and intramuscular, long-acting oxytetracycline
virus DNA was not detected in fresh cutaneous lesions or EDTA blood and antibodies to LSD were not detected in serum.
Microbiology, microscopy and histopathology were performed at VETLAB Gribbles Veterinary Pathology, Glenside SA. Bacterial cultures identified light growths of Actinobacillus sp., Staphylococcus hyicus and other mixed organisms. The pathologist noted marked focal ulceration of the epithelium and abundant serocellular crust. The dermal architecture had been replaced by multiple coalescing pyogranulomas with central lytic necrosis and Splendore Hoeppli material. The lesion was summarised as dermatitis, necrotizing, pyogranulomatous, moderate, multifocal, chronic with intralesional Splendore Hoeppli.
The steer was diagnosed with a cutaneous form of Actinobacillosis. The skin lesions were caused by Actinobacillus sp., possibly with some fungal and other bacterial co-infection. Treatment with sodium iodide, antibiotics and anti-inflammatories was effective as lesions were significantly smaller at the two-week revisit and almost completely resolved 6 weeks after the second dose of sodium iodide.
The bacteria Actinobacillus is a normal inhabitant of the oral cavity of ruminants but is known to cause opportunistic infections. Infections of the tongue (commonly referred to as ‘wooden tongue’), gums and oral cavity of cattle are seen regularly in practice, often as a result of damage to the oral mucosa from grazing rough feed. Actinobacillus has the tendency to invade

soft tissues, often spreading to regional lymph nodes of the head and neck. Infection may also extend to subcutaneous tissue and the skin, causing granulomatous ulceration. Atypical or cutaneous forms of infection are rare but have been reported in overseas cattle.1, 2, 4, 5 It is often a disease seen in individual animals, as in this case; however, herd outbreaks have also been reported.³
Actinobacillus is not believed to survive readily in the environment so the more likely cause of infection in this case is from abrasions in the oral mucosa from rough feed or alternatively bacteria gaining entry through cows licking open skin wounds. Actinobacillosis typically responds well to sodium iodine therapy and/or long-term
antimicrobial treatment and this case supports this type of treatment for cutaneous forms.
This is a good example of an unusual case where the veterinarian worked closely with government officials to facilitate disease investigation and importantly, rule out any potentially notifiable or exotic diseases.
1. Caffarena RD, Rabaza A, Casaux L, Rioseco MM, Schild CO, Monesiglio C, Fraga M, Giannitti F, Riet-Correa F. (2018) Natural lymphatic (“atypical”) actinobacillosis in cattle caused by Actinobacillus lignieresii. J Vet Diagn Invest . Mar;30(2):218225. doi: 10.1177/1040638717742621. Epub 2017 Dec 4. PMID: 29202671; PMCID: PMC6505872.
2. Cahalan SD, Sheridan L, Akers CR, Lorenz I, Cassidy J. (2012) Atypical cutaneous actinobacillosis in young beef cattle. Vet Rec Oct 13;171(15):375. doi: 10.1136/vr.100906. Epub 2012 Aug 22. PMID: 22915684.
3. Davies M. Two “outbreaks” of Actinobacillosis in beef cattle. Flock & Herd. 2015.
4. Margineda, C. A., Odriozola, E., Moreira, A. R., Cantón, G., Micheloud, J. F., Gardey, P., Spetter, M., & Campero, C. M. (2013). Atypical actinobacillosis in bulls in Argentina: granulomatous dermatitis and lymphadenitis. Pesquisa Veterinária Brasileira 33(1), 1–4. doi.org/10.1590/S0100736X2013000100001
5. Rebhun WC, King JM, Hillman RB. (1988) Atypical actinobacillosis granulomas in cattle. Cornell Vet. Apr;78(2):125-30. PMID: 3371003.
6. Relun A, Cesbron N, Bourdeau P, Dorso L, Brement T, Assié S, Christensen H, Guatteo R. (2019) Atypical actinobacillosis affecting hind limbs and lungs in a single beef cattle herd J Vet Intern Med. Jan;33(1):297-301. doi: 10.1111/jvim.15387. Epub 2018 Dec 12. PMID: 30548325; PMCID: PMC6335530.

1 February - 30 November 2025
Tutor: Paul Cusack
BSc BVSc (Hons) MVSt MAgribus PhD FACVSc
Outstanding tutor who helped me whenever needed. -Clayton Knight, QLD
Aine Seavers MVB MRCVS Vets1laser, Australia
e. aine@vets1laser.com
Perspective No. 164
Hypothyroidism is one of the most common canine endocrine diseases, but perhaps also the most misdiagnosed writes Dr Aine Seavers who has particular interests in the fields of thyroid disease, toxicology and photobiomodulation.
It is critically important that thyroid function tests should only be performed in dogs with physical findings and clinical signs consistent with hypothyroidism.
However, because of the abundance and ease of on-site testing kits, more and more dogs are being tested for this condition, not because they have signs suggestive of the condition, but simply because the serum thyroid TT4 tests are so omnipresent in so many on-site clinic blood profiles. The result of which – from what is often one test, sampled from one moment in time – is often taken at face value, and drug supplementation therapy subsequently instigated.
The problem is that the long-held view of thyroxine as a ‘safe’ hormone, hard to harm with, and cheap and easy to give, is under challenge. We wouldn’t run dogs on an insulin, oestrogen or stilboestrol hormone trial with the quite the same laid-back nonchalance as is done with thyroid hormone; yet few are concerned about inappropriate, even life-long use of this thyroid medication in many dogs, often without a definitive diagnosis.
Granted the situation is a complicated one, not least because thyroid hormone affects metabolic processes in all body systems and so hypothyroidism potentially can produce multiple non-specific clinical signs.
A definitive diagnosis of hypothyroidism is further complicated by the lack of readily available and affordable diagnostic tests that demonstrate acceptable sensitivity and specificity.
The clinician must first recognise clinical features that are not invariably characteristic and use confirmatory laboratory tests which can be difficult to interpret, especially in the presence of non-thyroidal illness or recent drug administration. An additional complication is that analytic techniques and reference intervals for different hormones vary from one laboratory to another.
It has become quite clear that reference ranges for a wide array of clinical and laboratory measurements in canine medicine are strongly influenced by breed, and this impacts on the interpretation of values for haematology and serum biochemistry (e.g., haematocrit, leukocyte counts,
cholesterol concentrations) and the results of hormone assay determinations. For example, it has been shown that Greyhounds have higher haematocrits and higher blood viscosity than non- Greyhounds; they also have a different ability to hepatically bio-transform certain drugs, e.g., the thiobarbiturates, and have extreme echocardiographic parameters and a propensity towards hypertension. However, a suggestion to apply the reference interval (RI) of Greyhounds to other sighthounds, based on similarities, has now been found not to be applicable for many sighthounds.
With regard to total thyroid hormone or TT4, concentrations (< 17 nmol/L) are suggestive of, but not diagnostic for, hypothyroidism, as subnormal TT4 concentration can be seen in healthy, euthyroid dogs. It has been proposed that several sighthound breeds have TT4 concentrations lower than the normal canine RI. TT4 concentrations in serum are lower than in ‘normal dogs’ in Greyhounds, Whippets, Scottish Deerhounds, Giant Schnauzers, conditioned Alaskan sled dogs, Sloughis, Basenji and Salukis, while higher values have been reported for the Polish Owczarek Nizinnys breed. Thus, TT4 concentrations by themselves have limited scope for determining thyroid function in these breeds.
The situation is thus further complicated when a specific breed society decides to screen breeding stock for hypothyroidism on the basis of an alleged inherited basis for the condition. Driven by ‘abnormal’ results, based on inappropriate laboratory reference intervals which do not take breed differences into account, a situation may arise where healthy individuals are unnecessarily removed from the gene pool on the basis of such testing.
Recommendations on the use of TT4 concentrations as prognostic indicators in dogs with non-thyroidal illness further emphasises the importance of referencing breedspecific concentration intervals for each patient. The failure to address breed-specific reference intervals can see prognostics of a particular ill animal so skewed that euthanasia of a survivable case occurs; such scenarios can result in legal action by owners against vets, as has already occurred in Australia.
Ambient temperature can affect serum thyroid levels. Circadian rhythm and time of day can also affect levels as can age, weight and breed.
Factors such as whether the dog is an indoor or outdoor dog, as well as the time of year, if Winter or Summer, can affect the endogenous levels. A European study showed ‘serum TT4 and fT4 concentrations had seasonal dependence in both outdoor and indoor dogs of all breeds. In dogs kept outdoors, this fluctuation was significant and quantifiably dependent on ambient temperature.’
Feeding may not affect the TT4 levels, but TSH is affected by feeding in the 12 hours preceding testing in humans.
So whether you fast the patient or not, the time of day, the ambient temperature, the full medical history, the genetics of the patient, and the patient’s current clinical status all must be factored into the ‘how’, the ‘when’, and ‘the what now?’ of thyroid blood testing.
This makes some investigators and many clinicians question whether it is indeed possible to diagnose canine hypothyroidism conclusively in some instances.
A large proportion of my general practice work in the last 20 years stemmed from somehow attracting to my practice sighthound breeder clients deeply invested in the health of the overall breed, rather than in the overall profit to be made from an individual breeding dog. Conflict arose because what the dogs were telling me as a clinician, and what the ‘powers-that-be’ told me the blood tests meant, did not match up. In the end, I believed my patients, and questioned the status quo on many aspects of hypothyroid diagnosis and dosage but especially the absence of breedspecific blood reference intervals and, more recently, the absence of breed-specific drug dose per kg guidelines and/or individualised induction regimes. The results of my investigations all have been peer-review published and cited.
As it might be helpful to other time-poor clinicians out there to have access to an abbreviated, more practicefocused version of that decade-plus of findings, I have put together a summary for other clinician colleagues.
Traditional therapeutic thyroxine supplementation trials as a diagnostic tool— maybe not!

While a therapeutic trial of thyroid supplementation is commonly used to determine the accuracy of a presumptive diagnosis of hypothyroidism, limitations exist because pharmacological actions of thyroxine can produce an improvement in ‘thyroxine-responsive conditions’ even in patients that are not actually hypothyroid. Such conditions can improve with thyroxine administration even when the patient is not hypothyroid.
There is a growing concern that a therapeutic thyroxine trial may not be as innocuous as was once presumed. In cases of illness and malnutrition, the body expresses ‘Low T3 Syndrome’ in which the production of T3, the most potent thyroid hormone, is down-regulated by suppression of the enzyme that converts T4 to T3. This reduced production is considered an adaptive mechanism, whereby the body acts to limit protein loss by decreasing metabolic rate during chronic or severe illness. Thyroxine supplementation in humans with severe non-thyroidal illness is currently also controversial and the subject of prospective studies.

Excess thyroxine supplementation in dogs can induce distressing side-effects including anxiety, panting, polydipsia, polyphagia, diarrhoea, pyrexia, and pruritus. Of particular concern is the patient with concurrent cardiac disease, where dose-related precipitation of heart failure has been documented. It would, therefore, seem prudent to exercise caution in supplementing dogs under similar circumstances, particularly in sighthounds which routinely function with normal lower serum TT4 concentrations than other breeds.
Thyroxine dosing issues have recently been reported in the human arena, where concerns have been raised regarding high thyroxine doses causing increased risk of bone fracture and atrial fibrillation in elderly patients. A dose-response relationship was documented in human patients, with the requirement for decreasing thyroxine dose with age.
A significant new observation is that actual hypothyroid sighthound Basenji dogs appear to require smaller doses of thyroxine for replacement therapy than ‘normal dogs.’ Currently recommended dose rates for thyroxine (10-20µ g/kg/day) produce unacceptable clinical signs including nervousness, tremor, head-bobbing, and tachycardia when administered to Basenji, irrespective of whether they are truly hypothyroid or not. These signs occur when post-pill serum TT4 concentrations are within, or just above, the TT4 RI for normal dogs. As a result, a therapeutic trial using thyroid replacement therapy is not as straightforward and innocuous as it is in other breeds.
The current advice, when managing definitively or presumptively diagnosed cases of hypothyroidism in a Basenji or other sighthounds, is to start with a low dose (e.g., 5µg/kg once daily), and increase the dose gradually, while closely monitoring for restlessness, head-bobbing, ataxia, etc. The final tolerated dose in Basenji is expected to be approximately 25 per cent to 50 per cent of the normal recommended thyroxine replacement dose for other breeds, producing serum TT4 concentrations in the RI for Basenji, but lower than the RI for ‘normal dogs’.
Genomic adversomics, a term for the genetic predisposition to adverse events, is germane to the issue of why Basenji exhibit dose-related sensitivity to thyroxine. The current drive in human medicine is to practice personalised medicine with predictive prescribing and drug doses tailored to the individual patient. This hinges on an appreciation of immunogenetics, and considerations such as knowing whether a patient is a high or low metaboliser. The Basenji breed-specific reaction to conventional recommended doses of thyroxine may represent a true genetically-programmed adversomic, potentially related to different kinetics of, or sensitivity to, thyroxine.
Personal communications from other colleagues who have a significant sighthound clientele of other breeds are suggestive that this drug dose intolerance may well be the case with other sighthound breeds as well. So, while the short half-life of T4 in normal dogs (12 to 24 hours) makes over-supplementation theoretically more difficult in dogs than in people, we now have concerns that the, as yet unknown, true pharmacokinetics of thyroxine in the Basenji or other sighthounds, compared to normal dogs, may cause significant issues with drug intolerance.
One possible way to reduce over-diagnosis is to use an rhTSH-human recombinant Thyroid Stimulation Test in dogs. This product is safe, easy and quick to use, and very accurate, but is potentially expensive if you don’t know the workarounds on safely storing it long term.
The reality is that while dynamic thyroid testing (previously carried out using chemical or bovine TSH) remains the ‘gold standard’ for thyroid function testing,³ the test has not been routinely performed for many years due to problems with sterility of TSH, the risk of acquiring prion disease from bovine TSH, and the general difficulty in accessing bovine TSH or chemical grade formulations.
However, these earlier TSH formulations have been replaced in recent times by rhTSH, a glycoprotein produced by genetic engineering.
This formulation appears very safe, allows for long storage (60-210 days frozen), is easy to administer and, in nonsighthound breeds, the results are very easy to interpret against a wide range of diagnostic interpretative criteria.
In Australia, rhTSH kits are available on individual order from Genzyme Sydney. While expensive per initial purchase (kit costs approximately $2,000 for 2 x 1.1mg vials of rhTSH), each kit does anywhere from 9-18 dogs depending on doses used.
A good scenario would be where one local practice buys the kit, then neighbouring practices purchase a couple

of individual vials each to share out the initial outlay cost. Recent work in 2024 by Belgian researchers shows exciting promise for using rhTSH to optimise treatment for Thyroid carcinoma in dogs by increasing tumor radioactive iodine uptake and hence treatment efficacy. Having an additional use for this medication to reduce wastage of the product and mitigate some of the overall cost of purchase may help make this product more accessible for testing our suspected veterinary hypothyroid patients.
Another option is to freeze the diluted vials as soon as the product is reconstituted. Freezing the dilute product in individual small vials for up to up to thirty weeks demonstrated the same intravenous post injection levothyroxine stimulation efficacy and the same high safety margin parameters as that of freshly-constituted rhTSH, resulting in significant shelf-life extension and efficacy of this dynamic stimulation agent.
A 1.1mg vial of rhTSH (in my case, Thyrogen; Genzyme, Sydney) is freshly prepared on Day One into 1.2 mL of sterile water to produce a 0.9mg/mL solution, following the manufacturer’s directions. The rest of the manufacturer’s instructions are to use within 24hrs of being diluted, therefore be aware that while peer-reviewed publications show safety and efficacy beyond that date, such use would be off-label so make sure your client signed consent form is clear and up to date.
Individual aliquots (0.06mL) of this solution are drawn up into insulin syringes (100U/mL; i.e., 6U = 0.06 mL = 54 µ g rhTSH). Insulin syringes are used to minimise dead space.
A blood sample is taken for pre-TT4 and pre cTSH levels from a 12-hour fasted dog. Individual aliquots of this fresh preparation are then administered IV to the dog.
The dog returns six hours after injection and a post-rhTSH blood sample is drawn.
The syringes, red rubber capped or single dose vials, can store frozen to be subsequently defrosted in the fridge as needed, allowed to come to room temperature, and then administered I/V.
Some overseas vets and researchers added 5 or 6mL of sterile water to the original vial and then used 0.5mL of this larger dilution to decant into insulin syringes, as they found it easier to use to measure out the dose. The larger volumes have been shown to be effective when frozen up to as long as 12 weeks.
Our vials, dispensed off an initial smaller volume dilution of 1.2mL, were stored frozen, also in zero dead space insulin syringes, and capped. These individual load syringes were used effectively out to 210 days and were easy to administer straight I/V by using a zero dead space insulin syringe to gain IV access.
Several different studies use different dose regimes. Up to 16kg weight, I use 54 µ g (0.06mL). I increase the dose by a factor of two or three depending on the size of the dog. A 2009 publication using a mixture of breeds recommended that dogs with concurrent disease or on medication should be tested with 150 µ g rhTSH (3x the dose used above) to improve differentiation between primary hypothyroidism and non-thyroidal disease. While correct, others have not found the same need to use so high a dose and a lower dose means more dogs can be tested from the same vial with better economics and no loss of accuracy.
results The rhTSH test results can be analysed using the following criteria:
a. TT4 levels throwing 1.5 x rise in TT4 levels (Dixon)
b. TT4 levels rising 24 nmol/l above baseline (Sauvé)
c. A rise in TT4 levels 20 nmol/l above baseline (Daminet)
d. TT4 levels increasing to above 40 nmol/l (Daminet)
e. TT4 levels increasing to above 45 nmol/l (Paradis).
f. Larsson’s equation;
Where the discriminant function k= 0.5 x pre-TSH T4 + [postTSH T4 – pre-TSH T4] T4 units = nm/l.
k > 30 rules out hypothyroidism, k < 15 suggests that hypothyroidism is likely.
k values of between 15–30 are non-diagnostic or equivocal.
For sighthounds, we have found Larsson’s equation applied to rhTSH testing currently shows great potential in assisting interpretation of dynamic thyroid testing results as it provides a buffer to better reflect a breed that suffers from such a normal low starting pre-stimulation TT4 value.
Values of k > 30 rules out hypothyroidism, while k < 15 suggests that hypothyroidism is likely.
k values of between 15 and 30 are non-diagnostic or equivocal.
As a result, in the absence of clinical signs but in the presence of ‘abnormal’ serum hormone blood results, utilising Larsson to interpret the results of dynamic testing has allowed us take the decision to avoid initiating supplementation for the ‘equivocals’ at that time. Larsson allows the clinician to avoid any untoward effects of thyrotoxicosis from un-necessary drug trials or drug therapy, and aids the clinician in the decision-making process as to whether or not to supplement a particular dog.
I have a basic table of all the criteria into which I insert the results and compare against all criteria to give a quick overall view of the individual animal’s test result.
In humans, monitoring serum TSH concentrations and TT4 concentrations concurrently is the preferred method of monitoring thyroid replacement therapy. A conceptually similar approach has been recommended by some veterinary researchers. The present author concurs with this approach for those breeds with a lower than ‘normal’ reference interval for serum TT4 concentrations as attempts to achieve a post-pill TT4 concentration achieved by normal dogs may induce clinical signs of thyrotoxicosis in these thyroxine-sensitive breeds.
Serial serum cTSH concentration determinations, with reduction of the cTSH concentration into the normal RI, provided additional evidence that thyroxine replacement therapy had been optimised in hypothyroid Basenji that only tolerated reduced oral doses of thyroxine. True hypothyroid Basenji stabilised clinically and the initially-elevated cTSH concentrations returned to within the normal RI during appropriate replacement therapy. At personalised, optimal thyroxine replacement dosing, serum TT4 concentrations of several dogs remained lower than TT4 RI for normal dogs, but their serial serum cTSH concentration determinations show reduction of the cTSH concentration into the normal RI, providing additional supportive evidence that thyroxine replacement therapy has been optimised.
The promotion in general practice of additional expensive thyroid tests perpetuates the myth of a thyroid epidemic and is of great concern.
Concerns arise re: the validity of the promotion of the age-sensitive thyroglobulin autoantibodies (TGAA) as a compulsory pre-breeding screen. Attention should be paid to the contemporary view of eminent endocrinologists that although TGAA positivity is suggestive of the potential for later development of clinical hypothyroidism, it does not establish the odds of the animal having hypothyroid offspring. This is a fact that breeders need to be made much more aware of in their decision-making in regards to selecting this test in breed screening blood panels. TGAA is also an expensive test because a single determination does not establish the animal’s current thyroid status and therefore is assayed annually from 12-30 months of age
until the animal is five years old. TT4 and cTSH tests are also required to be run in parallel to ‘verify’ the TGAA result. Importantly, a positive antibody test merely suggests the possibility of lymphocytic thyroiditis; it is not a thyroid function test. The presence of thyroiditis therefore does not signify a diagnosis of hypothyroidism (nor the need to supplement in the presence of a normal TT4). Indeed, only 20 per cent of patients with a positive TGAA test will progress to a hypothyroid state within a year. In one study of 234 dogs with antithyroglobulin antibodies over a 12-month period, 20 per cent developed changes in fT4 and/or cTSH suggestive of hypothyroidism, 15 per cent reverted to antithyroglobulin antibody negative status (with no change in fT4/cTSH levels) while 65 per cent remained antithyroglobulin antibody positive (or inconclusive—with no change of fT4/ cTSH).
TGAA is also not recommended in dogs older than six years yet this distinction is not observed by some laboratories.
Equally, the test kit accuracy of some laboratories was affected by vaccination or oestrus in the previous 100 days, yet was often done on a bitch peri-season and/or recently vaccinated or in elderly stud males. The resultant scenario, when this test came back in vogue some years ago, was that I had distressed breeders contacting me with the need to remove important breeding lines from small gene pools on the basis of this TGAA test. I advised caution and to have their vet redo the female’s test 100 days later while observing complicating factors—the bitches came back in clear. The male dogs had other testing done which came back normal. The same dogs bred well for several years after and never showed signs of hypothyroidism.
So, I don’t routinely use this TGAA test and was glad to read in both 2015 (Randolf et al) and 2021 (Taszkum et al)that this test continues to remain less important than TT4, cTSH and FT4.
Thyroid scintigraphy had been suggested as a more suitable ‘gold standard’ for determining thyroid status in dogs with low serum TT4 concentrations but is simply not practical in a general practice setting wherein the majority of thyroid testing is undertaken. Recent work suggests further studies are needed to evaluate this expensive and difficult to access modality; there are concerns that measurements

Figure 4. Small breeds have higher TT4 concentration than larger breeds such as the German Shepherd
– Circadian rhythm.
– Test between 10-2pm when TT4 naturally high (my preference is 10am-12pm).
Seasons
– Watch for season (and being in season).
Housing
– Whether patient housed indoors or outside.
– Ambient temperature if housed outside especially if a medium breed meant lower values in summer and higher in winter. (RCT Beagles show a different result). This differs from humans where the value is lower in cold weather.
Exercise
– Exercise level-training won’t affect the values.
Work
– Police dog work, for example, has a smaller impact on hormone concentration compared to intensive sport activity.
– Endurance events are believed to affect the values. However, endurance breeds like the Alaskan Sled Dog retain lower thyroid levels even when retired, so again both the breed and lifestyle must be factored into a decision re need for therapy
Breed
– Body size: small breeds have higher TT4 concentrations than larger breeds, e.g., French Bulldogs return higher normal TT4 values compared to a German Shepherd. Breed-specific exceptions exist, i.e., Giant Schnauzer, Deerhounds etc., so always factor breed into any interpretation.
Age
– Nursing pups have higher TT4.
– Older dog has lower TT4.
made using the gamma-camera may be non-diagnostic, asymmetric uptake can occur normally, and some drug therapies interfere or suppress thyroidal uptake of technetium and alter hormone concentrations in serum.
My personal experience has made me focus more and more on TT4 paired with cTSH, and often repeated serially to see a pattern. TT4 paired with cTSH along with FBC and
– Reduced in sepsis.
– Obese euthyroid dogs have higher TT4 values so an obese dog with a low indeterminate result has a higher level of suspicion of being truly hypothyroid.
– In healthy dogs >25kg, concentrations of fT4 and TT4 decrease and cTSH increases with age > 6 yrs.
“If feasible, dogs given medications known to affect thyroid function should not even have thyroid testing performed, because it is likely to result in inaccurate test interpretation and potentially unnecessary treatment” (Panciera).
For an up-to-date review of interfering medications, download the free pdf from JIVM 2023 by Bolton & Panciera: Influence of medications on thyroid function in dogs.
Drugs that don’t interfere with TT4: Potassium Bromide; Pexion—at least to 18 weeks; Cephalexins.
Photobiomodulation/Class 4 lasers can have impacts on the diseased thyroid gland. While we have been taught to avoid this area as a general rule when using laser/PBM therapy, the more recent articles now suggest that PBMT does not cause morphological changes on the healthy thyroid gland. However, in the diseased thyroid gland, PBM therapy can have a beneficial effect.
In one study in humans, use of PBMT caused a reduction in the daily dose of thyroid medication. Given that PBMT targets and modulates inflammation, and given so many thyroidal diseases are inflammatory or immune-mediated in nature, it makes sense that PBMT would be beneficial rather than detrimental in these cases.
However, if your patient is on PBM therapy for any reason be alert that the therapy can alter serum thyroid levels enough that a marginal hypothyroid case could be missed. If you do run a thyroid test, just factor in any interference in your serum blood level result (clarification: do not use the laser anywhere near any neoplastic lesion, even if it is a tumour in the thyroid gland, i.e., cats).
cholesterol as a minimum is analysed. T3 would be added for sighthound breeds.
For screening in suspected cases, I take fasting samples on a day where ambient temperature is not excessive (< 28°C) and on those days the blood is harvested before noon.
I stay with the laboratory I started with so I can minimise laboratory variables. I find out the days the laboratory runs their hormone panels—often only once a week. I then
harvest my patient’s screening blood test the day before, or morning of, the laboratory’s assigned day to ensure my bloods are not sitting there over a week before analysis. Doing so removes a heap of variables from the result and ensures my own personal library of thyroid serum results have all been collected etc. under similar conditions. I then compare the results against the clinical status of the animal, its age, breed, size, living conditions, and previous medications and supplements. If the results are inconclusive and I have access to rhTSH, I will do that either Day One, or some weeks later if the dog is not progressing as expected.
If the blood results and the clinical status are highly suggestive of hypothyroidism then I will instigate a clinical trial for three months.
For all dogs, regardless of breed, I titrate the dog up to standard doses over a two-week period (the only exception is pre-existing neurological/myxoedema coma scenarios where induction is fast). Slow titration allows you to pick up the drug intolerance or sensitive patients early in their distress.
Three months later, I post-pill test 4-6 hours later as a minimum. Sometimes, I will do a trough level as well, 12hrs or 23hrs pre-pill, depending on dose frequency. For sighthounds, I will include post-pill TSH levels whereas for other breeds I mostly only do TT4.
If the post-pill cTSH is back to normal and the dog is clinically well but the TT4 is not in the RI for non-breed specific TT4, I don’t change the dose.
I accept my approach is not standard. I simply share it with others in case it might explain hypothyroid complications and conundrums practitioners have had, for example, where the use of pre-existing protocols did not resolve the issue, as was the case for several of my patients.
Think before you thyroid test any canine patient.
Standardise how you harvest and process your samples.
Interpret the actual TT4 tests against complicating factors as detailed in this article.
Bolton A, Panciera DL. Influence of medications on thyroid function in dogs: An update J Vet Intern Med 2023 SepOct;37(5):1626-1640. doi: 10.1111/jvim.16823.
Epub 2023 Jul 27.
Boretti FS, Sieber-Ruckstuhl NS, Wenger-Riggenbach B, Gerber B, Lutz H, Hofmann-Lehmann R, Reusch CE. Comparison of 2 doses of recombinant human thyrotropin for thyroid function testing in healthy and suspected hypothyroid dogs J Vet Intern Med 2009; 23:856-861.
Daminet S, Fifle L, Paradis M, Duchateau L, Moreau M. Use of recombinant human thyroid-stimulating hormone for thyrotropin stimulation test in healthy, hypothyroid and euthyroid sick dogs. Can Vet J 2007; 48:1273–1279.
De Roover K, Duchateau L, Carmichael N, et al. Effect of storage of reconstituted recombinant human thyroid- stimulating hormone (rhTSH) on thyroid stimulating hormone (TSH) response testing in euthyroid dogs. J Vet Int Med 2006;20:812-817.
Dixon RM, Mooney CT. Evaluation of serum free thyroxine and thyrotropin concentrations in the diagnosis of canine hypothyroidism J Small Anim Pract 1999; 40:72-78.
Ferguson DC. Thyroid hormones and antithyroid drugs. In: Riviere JE, Papich MG, editor. Veterinary Pharmacology and Therapeutics . 9th edn. Wiley Blackwell, Iowa 2001; 29:745.
Fialkovičová M , Mardzinová , Benková et al. Seasonal influence on the thyroid gland in healthy dogs of various breeds in different weights. ACTA VET. BRNO 2012, 81: 183–188; doi:10.2754/ avb201281020183
Larsson M. Determination of free thyroxine and cholesterol as a new screening test for canine hypothyroidism. J Am Anim Hosp Ass 1988; 24:209-217.
Mooney C.T, Shiel RE, Dixon RM. Thyroid hormone abnormalities and outcome in dogs with non-thyroidal illness J Small Anim Pract 2008; 49:11-16 1991;2:125-132.
Panciera DL. Is it possible to diagnose canine hypothyroidism? J Small Anim Pract 1999; 40:152-157.
Paradis M, Lepine S, Lemay S, Fontaine M. Studies of various diagnostic tests for canine hypothyroidism. Vet Dermatology 1991; 2:125-132.
Randolf et al: Free thyroxine concentrations by equilibrium dialysis and chemiluminescent immunoassays in 13 hypothyroid dogs positive for thyroglobulin antibody. J Vet Intern Med 2015 MayJun;29(3):877-81. doi: 10.1111/jvim.12573.
Scheemaeker S, Peremans K, Vandermeulen E, Duchateau L, Roggeman T, Daminet S. Effect of recombinant human thyroid stimulating hormone on radioactive iodine uptake by thyroid carcinoma in dogs. J Vet Intern Med. 2024 Jul-Aug;38(4):2273-2281. doi: 10.1111/jvim.17132. Epub 2024 Jun 21. PMID: 39023205; PMCID: PMC11256155.
Seavers AM Vickery K, Page S, Weingarth M, Malik R. Dynamic thyroid testing, thyroid histology and thyroxine replacement therapy in Basenji dogs A.V.P 2015 (4):155- 162
Taszkum et al, Serum TT4, fT4 and TSH concentrations in German Shepherd dogs depending on age and type of work Pol J Vet Science 2021;24:63-86.

For further reading references cve.edu.au/p164
For your dedication and commitment, especially when juggling study commitments with work and family, to complete this vigorous but rewarding continuing education. —CVE Tutors & Staff
Tutors: Christina Dart & Eduardo Uquillas
—Fundamentals
Carmen Ali, Australia
Kaylee Bohaychuk-Preuss, Canada
Pinprakrom Chaikongkiat, Thailand
Denis Denais, Australia
Emily Gray, Australia
Chotipol Hannarong, Thailand
Kamolsri Lappolpaibul, Thailand
Gabrielle Livy, Australia
Chona Marie Ma, Philippines
Catherine McDonough, Australia
Helen McLean, Australia
Jennifer Myers, Australia
Cassandra O'Callaghan, Australia
Carol O'Donoghue, Australia
Emma Robb, Australia
Patitta Ruayaree, Thailand
Jodie Spence, Australia
Rebecca Teoh, Australia
Lai Man Ting, Hong Kong
Gezzel Yong, Australia
—Compromised Patients
Chotipol Hannarong, Thailand
Chelsi Kuebler, Australia
Joyce Lin, Singapore
Catherine McDonough, Australia
Nuttawadee Ngamlertwong, Thailand
Emma Robb, Australia
—Large Animals
Ayoub Aljadaan, Saudi Arabia
Thalita T Faria, Saudi Arabia
Michylla Seal, Australia
Christopher Shirley, Australia
Karhlia Smith, Australia
—Unusual Pets
Maddy Afford, Australia
Anna Di Tullio, Australia
Emily Gray, Australia
Chotipol Hannarong, Thailand
Tina Lee, Australia
Michael Ng, Australia
Pawit Punyarit, Thailand
Emma Robb, Australia
Rebecca Teoh, Australia
Sarah Wong, Singapore
Behavioural Medicine
Tutors: Kersti Seksel, Debbie Calnon, Jacqui Ley, Barbara Lindsay, Sally Nixon & Isabelle Resch
Melissa Barbuto, Australia
Zara Boland, Australia
Fauve Buckley, Australia
Olivia Bury, Australia
Laura Crowley, Australia
Malishka Fernando, Australia
Lauren Fletcher, Australia
Celia Gaches, Australia
Maria Jaccard, Australia
Jackson Kyle-Little, Australia
Yip Bun Leung, Australia
Annette Lockley, Australia
Joshua Lynch, Australia
Emily Mackle, Australia
Philip Macpherson, Australia
Amber Miller, Australia
Courtney Simmons, Australia
Tina Zhong, Australia
Cardiorespiratory Medicine
Tutors: Niek Beijerink & Mariko Yato
Ellen Bailey, Australia
Kijapat Charoenphongsakun, Thailand
Su Lin Chionh, Singapore
Doris Cho, Hong Kong
Rianna Dinon, Australia
Justin Fan, Hong Kong
Kathy Gillies, Australia
Victoria Groves, Australia
Cheah Kim Tho, Malaysia
Megha Lim, Australia
Kylie Mclaren, Australia
Arunothai Muangma, Thailand
Rutendo Mukandi, Australia
Suweeraya Nachamroen, Thailand
Sunipad Prommool, Thailand
Cath Rampton, Australia
Chawanwith Samachikthummakun, Thailand
Kelly Scott-Smith, Australia
Setthakorn Supparatpinyo, Thailand
Narumon Witayasuwanaporn, Thailand
Mookrawee Worapakdee, Thailand
Clinical Pathology
Tutors: Sandra Forsyth & Karen Jackson
Christopher Høstmælingen, Norway
Esmee Koh, Singapore
Kerry McNamara-Spackman, New Zealand
Adriana Wawrzyniak, United Kingdom
Dermatology
Tutors: Ralf Mueller, Sonya Bettenay & Stefan Hobi
—Advanced
Yanisa Aekworapong, Thailand
Watcharit Bawornnantiwat, Thailand
Pimpisa Chantui, Thailand
Anja Engelund, Denmark
Andrea Sinewe, Germany
Punyaphorn Suerngamieam, Thailand
Nusba Therakul, Thailand
Christiane Weingart, Germany
Olivia Williams
Gun Wongmongkol, Thailand
Wasaporn Worapunyaanun, Thailand
—Infectious Skin Disease
Yanisa Aekworapong, Thailand
Watcharit Bawornnantiwat, Thailand
Kate Boyd, Australia
Pimpisa Chantui, Thailand
Anja Engelund, Denmark
Thawiphorn Kaeseelohit, Thailand
Pranpariya Lertponrat, Thailand
Andrea Sinewe, Germany
Eleanor Street, Australia
Punyaphorn Suerngamieam, Thailand
Nusba Therakul, Thailand
Christiane Weingart, Germany
Priyanka Welsman, Australia
Gun Wongmongkol, Thailand
Wasaporn Worapunyaanun, Thailand
—Pruritic Skin Disease
Yanisa Aekworapong, Thailand
Watcharit Bawornnantiwat, Thailand
Pimpisa Chantui, Thailand
Elise Cooper, Australia
Anja Engelund, Denmark
Jacqueline Escobar, Australia
Pasirakan Paozeng, Thailand
Vidya Ramesh Pillai, Australia
Maddy Rose, Australia
Andrea Sinewe, Germany
Sandra Smith, Australia
Eleanor Street, Australia
Punyaphorn Suerngamieam, Thailand
Rhyanna Tedesco, Australia
Nusba Therakul, Thailand
Christiane Weingart, Germany
Priyanka Welsman, Australia
Olivia Williams
Gun Wongmongkol, Thailand
Wasaporn Worapunyaanun, Thailand
—Abdominal
Tutor: Zoe Lenard
Wittawat Atijatuporn, Australia
Munchupa Budphet, Thailand
Elise Ellis-Cluff, Australia
Robert French, Australia
Kaitlyn Iversen, Australia
Pavel Kagan, United Kingdom
Emma Lane, Australia
Tsz Lum Antonia Lee, Australia
Ruobai Li, Australia
Xiaotong Liang, Australia
Helen Marks, Australia
Emma McCarthy, Australia
Beth Metcalfe, Australia
Briar Morton, Australia
Rajiv Poorun, Australia
Meg Redenbach, Australia
Courtney Simkin, Australia
Johan Steyn, Australia
Valencia Jia Xuan Tan, New Zealand
Sonia Treagus, Australia
Lyddy van Gyen, Australia
Brianna Whitlock, Australia
Angelene Hooi Xian Woo, Australia
—Musculoskeletal
Tutor: Xander Huizing
Gaudiosa Berdon, Philippines
Munchupa Budphet, Thailand
Shirley Chow, Australia
Leah Dornin, Australia
Raymond Gates, Australia
Cameron Jones, Australia
Pipat Kosinwatana, Thailand
Ching Wai Law, Australia
Ruobai Li, Australia
Natalia Li, United Kingdom
Xiaotong Liang, Australia
Helen Marks, Australia
Deshaylia Moodley, Australia
Garwai Phan, Australia
Rajiv Poorun, Australia
Yustina Roman, Australia
Run Sakulsirajit, Thailand
Dana Seymour, Australia
Chun Fung Wong, Australia
—Thoracic
Tutor: Belinda Hopper
Ali Ashrafi, ACT
Kellie Anset, Australia
Hailey Benevides, Australia
Gaudiosa Berdon, Philippines
Liam Brown, Australia
Munchupa Budphet, Thailand
Vivian Chan, Australia
Christine Chang, Australia
Andrew Daniels, Australia
Stephen Fleischer, Australia
Zoe Fleming, Australia
Camilla Forss, Australia
Rebecca Fusaro, New Zealand
Raymond Gates, Australia
Jane Gibbs, Australia
Olivia Heggie, Australia
Jessica Ibey, Canada
Kaitlyn Iversen, Australia
Veronica Law, Hong Kong
Jo-Ching Lee, Australia
Jessica Leppard, Australia
Ruobai Li, Australia
Helen Marks, Australia
Gunilla McPherson, Australia
Alexandra Pentecost, Australia
Wai Yi Phooe, Myanmar
Run Sakulsirajit, Thailand
Dana Seymour, Australia
Philippa Simms, Australia
Vivian Tran, Australia
Lyddy van Gyen, Australia
Jessie Varker, Australia
Dallas Barker, Australia
Tutors: Yenny Indrawirawan, Sophia
Morse
Daphne Ang, Singapore
Sophie Bennett, Australia
Muhammad Dzul Ikraam Bin Ab Rahman, Malaysia
Elisha Joice Calixtro, Philippines
Richard Cameron, Australia
Hester Huang, Australia
Gail McDowell, Australia
Nattaporn Prayoonthong, Thailand
Claire Rose, Australia
Alison Simmons, Australia
Pik Wan, Australia
Suet Yi You, Australia
Tutors: Rachel Korman, Lara Boland, Katherine Briscoe, Michael Linton, Katie
McCallum, Myles McKenna, Carolyn
O’Brien, Kerry Rolph, Ashlie Saffire,
Samantha Taylor & Jane Yu
Jenni Aalto, Finland
Vivianne Albuquerque, Qatar
Francesca Alsworth, United Kingdom
Christina Ball, United States
Elizabeth Boyd, United States
Rachel Bridger, Australia
Tegan Brown, Australia
Eleanor Buchanan, United Kingdom
Tak Shing Cheng, Hong Kong
Hoi Mei Cheung, Hong Kong
Jiluttitikarn Choungboonsri, Thailand
Lai Ki Chung, Australia
Angel Coates, United States
Alana Costi, Australia
Ebony Crump, Australia
Ana Cuadrado, Spain
Domitilla De Cristofaro, France
Anna Di Toma, United Kingdom
Miriam Dieperink, Netherlands
Bárbara Durão, Portugal
Alison Edwards, Australia
Nicole Elias, Australia
Samantha Elliott, Australia
Cindy Favaro, Canada
Crystal Force, United States
Caitlyn Gallagher, Australia
Paige Ganster, United States
Kathrine Gibson, United States
Sadie Griffin, Canada
Emma-Gael Griffith, United Kingdom
Ann-Catrin Hagblom, Sweden
Zoe Healey, Australia
Brittany Hellems
Nikita Horn, Australia
Jenny Jensen, Denmark
Laura Jesus, Portugal
Helga Jorritsma, Netherlands
Phailin Kawijai, Thailand
Elina Kiiskinen, Finland
Elissa Kluger, Australia
Joanna Kluska, Poland
Laura Laihonoja, Finland
Kinza Larmor, Australia
Frances Lee, Australia
Ewa Lessen Kuhar, Croatia
Timothy Lim Cheng Hock, Malaysia
Kwei-Farn Liu, Australia
Katie McClaine, United States
Holly Monke-Eades, United States
Ashleigh Murray, Australia
Joanna Navotni, United Kingdom
Telisha Noller, Australia
Suphachot Phikultipsakorn, Thailand
Amanda Phillips, Australia
Rachel Poon, United Kingdom
Aishwarya Ramesh, India
Kristine Rice, United States
Melissa Rigby, Australia
Sergio Rios, Spain
Alicia Rubio, Peru
Rebecca Ryan, Australia
Penphicha Sangsawangchot, Thailand
Supakorn Sawangwong, Thailand
Timothy Tan, Australia
Lai Man Ting, Hong Kong
Lih-Yun Ting, Taiwan
Eva Trevino, United States
Lenka Veverkova, Czech Republic
Grace White, United States
Nicola Whitney, Australia
Shelli Wolfe, United States
Nisama Wongnitipat, Thailand
Celena Wu, Canada
Kristin Zajaczkowski, Canada
Ying Zheng, Australia
Internal Medicine: A Problem Solving Approach
Tutors: Jill Maddison, Sue Bennett & Susan Carr
Alice Boland, Australia
John Bonnici, Australia
Emily Boshammer, Australia
Alice Bowden, Australia
Julie Brown, Australia
Tori Carroll, Australia
Jessica chi ka Cheung, Hong Kong
Thanakon Chuachote, Thailand
Eliza D’Arcy-Moskwa, Australia
Julie-Anne Daly, Australia
Elizabeth Duncan, Australia
Gianne Ficatas, Australia
Amanda Fischmann, Australia
Rebecca Flegg, Australia
Lauren Golding, Australia
Jemima Jansen, Australia
Jenny Ji, Australia
Amber Jurek, Australia
Jessica Kopp, Australia
Freddie Lam, Australia
YIN PING LAU, Hong Kong
Yuting Li, Australia
Nicole McIntosh, Australia
Amy Menendez, Australia
Jamie Russell, Australia
Emma Tinslay, Australia
Jade Wilson, Australia
Amy Yap, Australia
Gezzel Yong, Australia
Amanda Young, Australia
Nuttawan Arsaikorn, Thailand
Tutors: Darren Merrett, Steve Holloway & Jen Brown
Ivana Bilic, Australia
Jessica Dalton, Australia
Rosemary Davis, Australia
Monique Einsiedel, Australia
Erin Gagliano, Australia
Pam Gillis, Australia
Catherine Harper, Australia
Matilda Hunter, Australia
Chi Yan Kan, Australia
Ubolbhorn Kankitpaisan, Thailand
Salinee Kongwee, Thailand
Shresta Maharaj, Australia
Nonsaporn Palawatvichai, Thailand
Hannah Passmore, Australia
David Porublev, Australia
Sean Quigley, Australia
Kristie Remmert, Australia
Suzana Ristic, Australia
Sarah Sabransky, Australia
Mananya Sakulchatwut, Thailand
Alison Siniawski, Australia
Chutinan Suwannasing, Thailand
Hamza Zaidi, Australia
Clinical Neurology
Tutors: Laurent Garosi & Simon Platt
Thunyathorn Charoenpichitnunt, Thailand
Jennifer Cormack, Australia
Ramita Kanjanakaew, Thailand
Sirawit Kitiphong, Thailand
Ken Robinson, Australia
Teerapong Rungruang, Thailand
Bheemawat Sompanish, Thailand
Karnchanarat Thanapakdeechaikul, Thailand
Annabelle Trimble, Australia
Kittichai Wannasiri, Thailand
Ophthalmology
Tutors: Robin Stanley
Supawadee Borwornchaiyarit, Thailand
Amy Brown, Australia
Melyssa Cotton, Australia
Elizabeth Davey, Australia
Lucas Grist, Australia
Jessica Jeffries, Australia
Lloyd Kenda, Hong Kong
Ruxsuda Khamrod, Thailand
Kamonphat Kongpom, Thailand
Nutnicha Muknumporn, Thailand
Pornchanok Panpakdee, Thailand
Benchaporn Phoonchako, Thailand
Sandra Smith, Australia
Kornkanok Sukchom, Thailand
Kulrada Tanachokkultorn, Thailand
Emily Wagler, Canada
Meghan Watson, Australia
Meng Joo Wong, Malaysia
Areeya Wongsurichai, Thailand
Anika Blackford, Australia
Practical Oncology
Tutors: Katrina Cheng
James Berman, Australia
Collette Berryman, Australia
Sofia Canala, Australia
Alex Fletcher, Australia
Lavanyah Sunmugam, Malaysia
Christiana Willenborg, Australia
Ruminant Nutrition
Tutor: Paul Cusack
Richard Bleckman, Australia
Carly Brownlow, Australia
Thomas Burke, Australia
Georgina Campbell, New Zealand
Frances Collett, Australia
Rebekah Densley, Australia
Evie Duggan, Australia
Christopher Duke, Australia
Tiffany Fitzpatrick, Australia
Leah Hirst, Australia
Emilee Johnstone, Australia
Sarah Maher, Australia
Renee Nesser, Australia
Kate Peffer, Australia
Marie Rowe, Australia
David Ryan
Hannah Schulz, Australia
Kristy Stone, Australia
Sarah White, Australia
Jackson Arkadieff, Australia
Tutors: Chris Tan, Mark Newman, Wendy
Archipow, Bronwyn Fullagar
Yu-An Chang, Taiwan
Timothy Chong, Australia
Amelia Choong, Malaysia
Georgina Davis, Australia
Edward Dawson, Australia
Kate Elder, Australia
Gemma Gresham, Australia
Marie Håkonsen, Norway
Kate Harvey, Australia
Dennis Hitchen, Australia
Florence Ho, Hong Kong
Jonathan Hoong, Australia
Pollawat Jariyarangsrirattana, Thailand
Hei Yeung Calvin Lai, Australia
Thitikan Lailaeiad, Thailand
Stephanie Lok Yee Li, Hong Kong
SHWU YUNN LIU, Malaysia
Petra Lucktong, Thailand
Jen Manester, Australia
Lisa Mason, Australia
Amy Munro, Australia
Frederic Oxenham, Australia
Georgia Peoples, Australia
Stephanie Reardon, Australia
Brianna Ritota, Australia
Sarah Steel, Australia
Maithreyi Sundaresan, Australia
Jocelyn Teo, Singapore
Anabel Thomas, Australia
Laura Voyage, Australia
Panyawat Wachirapongpakorn, Thailand
Wing Tung Wong, Australia
Tony Xiao, Australia
Lucy Zhao, Australia
VPOCUS: Practical Applications for GPs Distance Education
Tutors: Soren Boysen & Serge Chalhoub
Clare ABeckett, Australia
Laree Alexander, New Zealand
Natania Beh, Australia
Clint Beutel, Australia
Charles Blackwood, Australia
Sara Brownhalls, Australia
Lin-En Chen, New Zealand
Simon Man Hon Cheung, Hong Kong
Kimberley Earl, Australia
Annie Geard, Australia
Jane Gibb, Australia
Veronica Gibb-Cumming, Australia
Barbara Henderson, Australia
Sarah Houseman, Australia
Kate Jackson, Australia
Barbara Jameson, Australia
Cindy Jarratt, Australia
Sarah Jobbins, Australia
Lisa Kavanagh, Australia
Kate Kellaway, Australia
Katherine Kirby, Australia
Julia Larsson, Australia
Benjamin Latham, Australia
Ching Wai Law, Australia
Sophia Lay, Australia
Pui Pui Betty Liem, Hong Kong
Hoi Yi Mak, Australia
Wayne Mizon, Australia
Brian Ng, Australia
Ranika Perera, Australia
Anne Quain, Australia
Craig Reeves, Australia
Valerie See, Australia
Elizabeth Thompson, Australia
Tobias Threadgold, Australia
Lucy Van Der Weide, Australia
Moira Van Dorsselaer, Australia
Helen Vanderbom, Australia
Ashleigh Wolfe, Australia
Leanne Yeung, Australia Congratulations to our 2025 Distance Education prize winners cve.edu.au/winners

Centre for

I completed the Surgery Distance Education course last year as part of my Memberships preparation which I’m sure was a major contributor to my success.
Centre for Veterinary Education
Elita Frazer, 2023 recipient of the CVE Paul Gotis-Graham Memorial Award for Excellence in Small Animal Surgery.
Note: This award is conferred by the ANZCVS Surgery Chapter to the person achieving the highest marks in the Surgery Membership examinations.
Distance Education courses are the ideal first step towards completing the ANZCVS membership exams and veterinary excellence.
Anaesthesia & Analgesia
Beef Production Medicine
Behaviour Medicine
Clinical Neurology
Clinical Pathology
Cardiorespiratory Medicine
Dermatology
Enrolments open till 31 January 2025
Centre for Veterinary Education cve.edu.au/distance-education
Diagnostic Imaging
Emergency Medicine
Feline Medicine
Internal Medicine: Keys to Understanding
Internal Medicine: A Problem Solving Approach
Ophthalmology
Surgery
